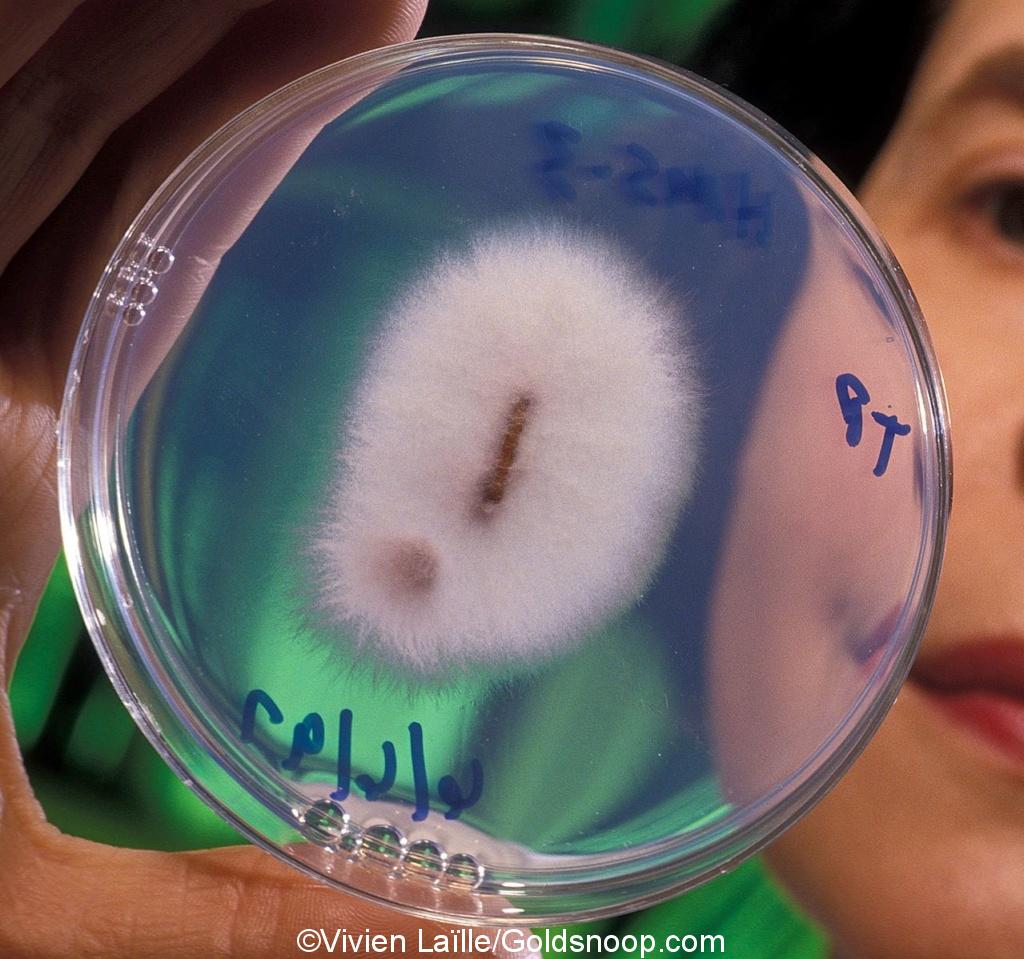

Cycle de l’or : géo-microbiologie et cycle biogénique de l’or (bactéries, champignons, archées, plantes)
Chers amis bonjour,
Merci pour vos messages, commentaires, courriels, toujours très nombreux, et très constructifs, cela est toujours motivant pour moi, car je souhaite vous partager et vulgariser toujours des concepts nouveaux et intéressants ! Merci pour votre confiance.
Dans cet article, votre fidèle et dévoué serviteur va tenter de vous expliquer et de synthétiser les principes de géo-microbiologie de l’or, et le cycle bio-génique de l’or, dans la nature.
Le Cycle de l’Or... tout un programme. Car oui ! Comme le Cycle de l’eau, le Cycle de l’azote, le Cycle du carbone, l’or a lui aussi son propre Cycle naturel.
Amis prospecteurs, sachez de la biologie et la vie naturelle des micro-organismes sont essentiels à la formation de gisements d’or secondaires.
Raison de plus pour prendre le plus grand soin possible des biotopes et des environnements naturels, au-delà des aspects écologiques et des exemples que nous devons montrer en tant que prospecteurs d’or, auprès des citoyens et des bienveillants politiciens et fonctionnaires.
En fait, sans la faune et la flore, il n’y aurait que très peu de gisements aurifères secondaires ; il est important de garder à l’esprit le rôle majeur des biotopes, qui sont, comme vous allez le voir, des moteurs et des vecteurs à la formation de paillettes et de grains d’or que vous trouvez au fond de vos pans ou sluices !
Mon but est de vulgariser certains concepts, afin de vous aider à mieux comprendre mais aussi de vous donner les arguments et les raisonnements pour vous donner l’opportunité de considérer, lire et observer la nature sous un autre angle, dans le cadre de vos recherches et prospections aurifères.
Pour résumer, d’abord vous expliquer quels sont les principaux types de gisements aurifères dans la nature. Puis je vais vous détailler le rôle majeur des bactéries, leurs interactions avec l’or, les processus bio-chimiques impliqués, la formation des gisements d’or secondaires, et comprendre pourquoi les paillettes d’or sont plus pures que l’or primaire…
Cette tentative d’explications est le fruit de plusieurs mois de recherches, de lectures, de synthèses, de traductions, de toutes les informations que j’ai pu trouver et regrouper à ce sujet. Cela m’a pris presque 1 an pour mettre en forme cet article avec soin, pour obtenir le résultat que je souhaitais. Après tout, c’est une passion, un plaisir ! J’ai dépensé (du temps) sans compter!
Il est essentiel pour les chercheurs d’or et les prospecteurs, de bien comprendre les principes énoncés dans cet article, afin d’ouvrir des nouveaux champs et perspectives d’explorations, mais aussi pour développer leurs intuitions, leurs interprétations et analyses sur le terrain.
Au delà, il y a aussi la prise de conscience du rôle vertigineux des bienfaits de la Nature dans le Cycle de l’or, et une remise en question philosophique sur notre place dans notre univers, dans notre monde, dans l’espace et le temps ; il y a une forme de beauté dans ces idées et concepts. Cela mérite réflexions.
Dans un but strictement éducatif et d’apprentissage, je cite, conformément à l’article 10.1 de la Convention de Berne, en bas de cet article, toutes les sources, illustrations, auteurs et contributeurs (dont je suis pour certains un très grand fan), toutes les thèses et publications, qui m’ont inspirés pour concevoir cet article.
Cela vous permettra à tous de continuer à explorer ce sujet très passionnant, et d’enrichir vos connaissances, du moins pour les plus curieux d’entre vous, je vous le souhaite.
Aussi, je vous invite préalablement à lire et à consulter des articles que j’ai récemment publié, et qui vont compléter ce dossier:
- Cours d’orpaillage: Géochimie, mobilisation et précipitation de l’or dans les cycles d’érosions,
- Cours d’orpaillage: Les types de gisements aurifères dans la nature,
- L’or: montre moi tes formes et tes couleurs, et je te dirais qui tu es et d’où tu viens!
Auteur: Vivien Laïlle – Téléphone: +33 (0)6 95 34 35 45 – Mail: vivien.laille@gmail.com.
Mots clefs: aurifère, chercher de l’or, chercheur d’or, gisement aurifère, gisement détritique, gisements aurifères, gisements métallifères, gold, gold mining, gold prospector, or, orpaillage, orpailler, prospecter, prospecteur, prospection aurifère, roche aurifère, roches aurifères
SOMMAIRE :
- Introduction
- La libération de l’or dans la nature grâce au weathering
- Différents types de gisements d’or primaires et secondaires
- Les gisements aurifères de types filoniens
- Les gisements aurifères de types skarn
- Les gisements aurifères de types magmatiques
- Les dépôts aurifères sédimentaires ou gisements aurifères secondaires
- Dépôts aurifères de types sulfures massifs volcanogènes (VMS)
- Gisements aurifères de types hydrothermaux
- L’analyse et l’observation de l’or aux multiples formes et couleurs
- Les caractéristiques géochimiques de l’or
- La bio-minéralisation de l’or et sa biochimie en interaction avec les bactéries
- Transformation de la morphologie des particules d’or
- Transport de l’or secondaire et cinétique du cycle bio-géochimique de l’or
- La vie organique en interaction avec l’or
- Les bactéries, des usines à nanoparticules d’or
- Liste des bactéries produisant des nanoparticules d’or (Au)
- Liste des bactéries produisant des nanoparticules d’argent (Ag)
- Les archées
- Les champignons
- Les plantes
- Les micro-organismes qui interagissent avec l’or
- Archée: Pyrobaculum islandicum
- Bactérie:Thermotoga maritime
- Bactérie: Chromobacterium violaceum
- Bactérie: Desulfovibrio desulfuricans
- Bactérie: Acidothiobacillus ferrooxidans
- Bactérie: Acidithiobacillus thiooxidans
- Bactérie: Bacillus subtilis
- Bactérie: Cupriavidus metallidurans, souche CH34
- Le cycle bio-génique de l’or
- Des bactéries et des micro-organismes, le biofilm bactérien
- Les horizons de l’or
- La genèse des pépites d’or
- Des bio-indicateurs pour chercher de l’or ?
- Lessivage / lixiviation de l’argent
- Minéralisations biogéniques aurifères
- Conclusions
- Références
- Web
- Thèses
- Livres
Un document PDF sur Le Cycle de l’or dans la nature, lors de la conférence Les Chemins de la Connaissance, en été 2022, à Saint-Lizier, en Ariège, en France.
VIDÉO : LE CYCLE DE L’OR DANS LA NATURE – conférence/cours d’orpaillage/prospection aurifère
Lien direct ici : https://youtu.be/Ct3NllHYTVE
Ci-dessous: les pères fondateurs de la micro-biologie et de l’immunologie moderne, l’allemand Robert Koch et le français Louis Pasteur, deux scientifiques rivaux et concurrents qui avaient pourtant les même buts et inspirations.
Ah ! Si ces deux scientifiques avaient pu collaborer et travailler en commun, ils auraient accomplis encore plus de grandes découvertes !
L’histoire en a décidé autrement… Ils ont notamment contribué à l’amélioration de techniques d’observation des bactéries et des microbes.
C’est le bactériologiste allemand Julius Richard Petri, un assistant du docteur Robert Koch, a inventé la boite de pétri, d’après une idée de Walther Hesse et sa femme Fanny, qui permet la mise en culture de bactéries et de microbes pour pouvoir les étudier.



Il est difficile de dire qui a inventé le microscope optique. On dit souvent que l’opticien hollandais Hans Janssen et son fils Zacharias Janssen fabriquèrent le premier microscope en 1595, mais ceci provient d’une déclaration de Zacharias Janssen lui-même au milieu du XVIIe siècle.
Un autre favori au titre d’inventeur du microscope est Galilée. Il a développé un occhiolino, un microscope composé d’une lentille convexe et d’une autre concave en 1609.



Ci-dessus : le microscope que j’utilise pour les observations détaillées des grains et des paillettes d’or, suite à mes prospections aurifères. Il est beaucoup plus moderne. Bien sur, il n’est pas assez puissant pour observer les micro-organismes. J’utilise un NOVEX P-20, mais vous pouvez très bien utiliser aussi un DINOLITE. L’observation des grains et des paillettes d’or au microscope permet de bien étudier leurs formes, de les analyser et d’obtenir des informations essentielles, comme leurs histoires, origines, genèses et parcours.
Ci-dessous: observations au microscope de paillettes et de grains d’or fin, très pur, en provenance d’un gisement aurifère détritique de type gisement secondaire. Ils ont été découverts dans une marmite, avec beaucoup de sables noirs et des objets en fer rouillés.
Ils sont le fruit d’actions et de phénomènes bio-chimiques découverts récemment par les scientifiques, grâce aux bactéries, végétaux et autres micro-organismes qui jouent des rôles essentiels dans la production de nano-particules d’or et dans le transport de l’or dans la nature.


Ci-dessous: des grains et des paillettes d’or, de dimensions millimétriques, tels qu’il est possible de les observer à l’œil nu ou au microscope. Ils ont été trouvés dans une faille de bedrock et dans une marmite, tout simplement.
Notez l’incroyable diversité des formes et des couleurs. Très souvent, l’or secondaire a un titre et un alliage plus pur que l’or primaire. Cela est une conséquence de l’action des micro-organismes dans les sols, qui jouent le rôle d’usines à raffineries de particules d’or.



Introduction
Le noyau terrestre contiendrait l’essentiel de l’or de la planète, jusqu’à 98 % du volume total. Il s’agit probablement de l’or initialement présent dans toute la planète, suite à l’accrétion planétaire.
Cet or aurait été concentré préférentiellement dans le noyau lors de la différenciation planétaire.
La teneur en or de la croûte et du manteau terrestres est cependant plus importante que celle supposée si l’accrétion et la différenciation planétaire sont les seuls processus invoqués pour expliquer la répartition de l’or dans la Terre interne.
En effet, la différenciation planétaire est un processus suffisamment efficace pour concentrer la totalité de l’élément dans le noyau.
Il y a 3 concepts ou notions essentielles à comprendre et à assimiler, avant d’entamer la compréhension du cycle bio-géochimique de l’or dans la nature :
- Le principe de weathering,
- Les principaux types de gisements aurifères, d’un point de vue géologique,
- Le principe d’observations au microscope des composants des sables noirs dans les concentrés aurifères et les observations des couleurs et des formes des grains et des paillettes d’or.
Je vais développer ces différents concepts ci-dessous.
La libération de l’or dans la nature grâce au weathering
Certes, l’or ne s’oxyde pas (comme le pourrait le fer par exemple ou d’autres métaux oxydables), mais il peut être dissout et solubilisé naturellement, par les actions et les réactions de composés chimiques divers et variés, ce qui permet sa mobilité, parfois sur de très longues distances.
Dans les environnements altérés par les intempéries (processus de weathering, d’oxydations et d’érosions des roches), l’or est mobilisé, sous la forme de complexes oxydés solubles ou de nanoparticules d’or élémentaires très petites et invisibles à l’œil nu.
C’est la somme de tous les événements exogènes successifs au fil du temps qui vont décomposer et éroder les roches hôtes aurifères et transporter l’or plus loin : l’eau, la pluie, le vent, le gel, la gélifraction, le monde végétal (racines, mousses, lichen, champignons), l’acidité ou l’alcalinité de l’environnement.
Les transitions de l’or entre les états aqueux (ions d’or aurique et ions d’or aureux en solution dans l’eau) et solide sont attribués à des conditions géochimiques variables, catalysées par la biosphère et par les organismes vivants.
Pour être complet à ce sujet, je vous invite à lire cet article intitulé : Cours d’orpaillage: Géochimie, mobilisation et précipitation de l’or dans les cycles d’érosions
Ces conditions géochimiques à prendre en compte sont par exemple :
- La quantité d’oxygène (milieu hypergène, milieux supergènes, milieux hypogènes),
- L’acidité ou la basicité du sol ou de l’eau, c’est à dire le pH (potentiel hydrogène) : acide ou basique (alcalin),
- Les variations de température,
- Les variations de pression,
- Les variations d’élécto-conductivité, ou EC,
- La présence ou non de catalyseurs de précipitation de l’or,
- La présence ou non d’éléments chimiques ou métalliques qui ont une grande afinité avec l’or (fer, cuivre, argent, manganèse…),
- La présence ou non de micro-organismes (bactéries, archées, lichens, champignons, plantes métallifères), dont les métabolismes sont dépendant de la présence de métaux dans les sols ou l’eau, y compris avec l’or lui même.
Voici les corps catalyseurs précipitant pour l’or dans la nature :
- Les sulfures altérés et oxydés: pyrites, chalcopyrite, blende, galène, arsénopyrite,
- L’acide carbonique, les carbonates,
- Le sulfate de fer,
- Les oxydes et hydroxydes de fer,
- L’acide humique,
- L’acide oxalique,
- Les hydrocarbures,
- La charbon,
- Le carbone,
- Le bitume,
- La lignite,
- La limonite,
- Les hydrocarbures,
- Le graphite,
- L’amphibole,
- Le feldspath orthose,
- La hornblende,
- Le manganèse,
- Les argiles et silicates,
- Les métaux réducteurs,
- Les corps supergènes.
La notion de métabolisme des micro-organismes implique les idées et concepts suivants :
- que l’or est une source d’énergie ou un vecteur d’énergie en tant que tel, via des réactions chimiques au sein de ces micro-organismes in-situ, qui permettent à ceux-ci de vivre et de s’épanouir,
- que l’or est un déchet, conséquence et résultat de la vie et de l’existence de ces micro-organismes. Très souvent des nanoparticules d’or.
- que l’or va être raffiné et purifié, et que ces micro-organismes sont des raffineries à or et jouent un rôle d’usines purificatrices d’or : elles vont augmenter la valeur de son titre, comparé à de l’or de gisements aurifères primaires.
Initialement, le cycle global bio-géochimique de l’or débute par la libération de particules d’or et d’argent disséminées dans une roche hôte, qui sont des gisements aurifères primaires, souvent d’origines hydrothermales, grâce à des altérations provoquées par l’oxydation et le weathering.
Dans la nature, ces processus sont immuables et permanents, et libèrent l’or et le transportent sur des grandes distances :
- soit sous une forme dissoute en solution aqueuse, sous la forme d’ions, pour précipiter à l’état solide en d’autres lieux, si les conditions physico-chimiques le permettent,
- soit sous la forme de particules d’or plus ou moins grosses et visibles au microscope ou à l’oeil nu, qui vont être transportés mécaniquement par les eaux fluviales et éluviales, et mobilisés par la gravité.
Ce qu’il faut retenir de ces processus d’oxydation et de weathering, d’érosion et de décomposition de ces roches hôtes de gisements aurifères primaires, c’est que, perpétuellement, les gisements d’or secondaires et détritiques dans nos rivières et nos placiers se renouvellent en permanence au fil des années, des saisons, des crues et du temps.
Ces mécanismes aboutissent à la formation des complexes chimiques solubles d’or inorganiques et organiques.
Cependant, en présence de microbes ou d’autres réducteurs, comme par exemple des argiles et des oxydes de fer, ces complexes chimiques aurifères peuvent être déstabilisés.
La réduction chimique de l’or soluble conduit finalement à la bio-précipitation et à la bio-minéralisation de l’or, dont le produit peut s’agréger en structures plus grandes, complétant ainsi le Cycle de l’or.
Les microbes peuvent avoir un effet profond et durable sur la présence d’or dans les environnements naturels, étant donné que les nutriments nécessaires au métabolisme microbien sont maintenus et que l’or est dans le système.
Différents types de gisements d’or primaires et secondaires
Pour être complet, il existe en tout une vingtaine de types de gisement aurifères sur Terre, chacun ayant leurs propres caractéristiques respectives.
Il n’existe pas de classification normalisée des gisements aurifères.
Les critères pouvant être utilisés sont nombreux (structure, roche encaissante, genèse, géochimie…) et varient selon les auteurs et les publications scientifiques.
La tâche est d’autant plus ardue que de nombreux gisements sont issus de différents processus géologiques successifs qui se superposent au cours du temps.
Je vous en présente toutefois quelques un ci-dessous ; d’ailleurs les limites et les frontières entre les caractéristiques ces différents types de gisements de dépôts aurifère sont parfois minces.
Très souvent, le type de gisement porte le nom de la mine ou de la localité concernée, en tant que modèle simplifié.
Pour compléter et aller plus loin, je vous invite à lire cet article, intitulé : Cours d’orpaillage: Les types de gisements aurifères dans la nature

En résumé, voici une liste des principaux types de dépôts de gisements métallifères aurifères primaires et secondaires :
- Gisements de nickel associés à la komatiite
- Dépôts d’intrusions mafiques-ultramafiques stratifiés
- Dépôts de skarn
- Dépôts associés à des granitoïdes fractionnés
- Dépôts associés au porphyre
- Gisements d’or de cuivre d’oxyde de fer
- Gisements hydrothermaux syn-déformationnels et de remplacement
- Gisements d’or orogéniques
- Dépôts stratoïdes de plomb-zinc hébergés dans des carbonates
- Gisements d’uranium liés à des discordances
- Dépôts de sulfures massifs volcaniques
- Gisements de métaux communs stratiformes hébergés dans des sédiments
- Dépôts de cuivre hébergés par des sédiments
- Formations de fer rubanées
- Dépôts sédimentaires de manganèse
- Gisements de bauxite
- Gisements de nickel-cobalt latéritiques
- Gisements d’or latéritiques et supergènes
- Dépôts supergènes associés aux paléocanaux
- Dépôts latéritiques de phosphate-REE-Nb
- Minerais de fer supergènes et gisements de canaux transportés
- Gisements d’uranium
- Gisements d’uranium réduits en paléocanal à « front de roulis »
- Gisements d’or de placer
- Dépôts de sable minéral lourd (placiers de sables noirs)
- Dépôts d’étain de placiers
Les gisements d’or sont généralement classés comme primaires ou secondaires.
Voici quelques explications et concepts à retenir et à comprendre, pour les plus gisements les plus courant ci-dessous.
Les gisements aurifères de types filoniens

Les gisements filoniens sont un type de gisement minéral constitué d’une zone localisée de minéraux remplissant les fractures.
- Ils se forment généralement dans des fractures ou des fissures dans la roche et se trouvent souvent dans ou à proximité de zones de failles, où les roches ont été fracturées et déformées.
- Les gisements filoniens peuvent contenir une variété de minéraux métalliques et non métalliques, notamment de l’or, de l’argent, du cuivre, du plomb, du zinc, de l’étain, du tungstène et de la fluorite, entre autres.
- Les dépôts filoniens se forment par divers processus, notamment l’activité hydrothermale, le métamorphisme et l’altération.
- Les minéraux qui composent les gisements veineux sont généralement déposés à partir de fluides hydrothermaux qui ont migré à travers la roche, souvent depuis les profondeurs de la croûte terrestre.
- Ces fluides peuvent être riches en minéraux dissous, qui peuvent se précipiter hors du fluide et former des dépôts filoniens lorsque les fluides se refroidissent et réagissent avec la roche environnante.
- Les dépôts filoniens peuvent être relativement petits ou s’étendre sur plusieurs kilomètres, et ils peuvent se produire dans une variété de types de roches, y compris des roches ignées, sédimentaires et métamorphiques.
- La taille et la teneur des gisements filoniens peuvent varier considérablement et leur viabilité économique dépend d’un certain nombre de facteurs, notamment la concentration des minéraux souhaités, la taille et la forme du gisement et le coût d’extraction et de traitement des minéraux.
- Les dépôts veineux peuvent être classés en plusieurs types différents en fonction de leur origine et de leur composition.
Certains des types courants de gisements filoniens comprennent :
- Veines hydrothermales : Ces veines se forment lorsque des fluides chauds (généralement de sources magmatiques) s’écoulent à travers les roches et que les minéraux contenus dans les fluides se cristallisent dans les fractures et les cavités de la roche hôte. Les veines hydrothermales peuvent être subdivisées en plusieurs sous-types en fonction de leur composition, telles que les veines de quartz, les veines de carbonate et les veines de sulfure.
- Veines de pegmatite : Ces veines sont composées de minéraux à grains extrêmement grossiers et sont formées de magmas très fluides et riches en eau. Les veines de pegmatite peuvent être une source de minéraux rares et précieux tels que le lithium, le tantale et le béryllium.
- Veines de zone de cisaillement : Ces veines sont formées par le mouvement des roches le long des plans de faille ou des zones de cisaillement. La pression et la friction intenses lors du mouvement des roches peuvent provoquer des écoulements de fluides le long de la zone, entraînant la formation de veines.
- Veines métamorphiques de contact : Ces veines se forment lorsqu’un corps de magma pénètre dans une roche préexistante, provoquant le chauffage et la recristallisation de la roche. Au fur et à mesure que la roche se recristallise, les minéraux peuvent se concentrer dans des veines le long de la zone de contact entre le magma et la roche hôte.
- Veines liées aux failles : Ces veines sont formées par le mouvement des roches le long des failles. Les fluides qui traversent la faille peuvent déposer des minéraux dans des fractures ou des espaces vides dans les roches adjacentes à la faille. Il existe également d’autres types de gisements filoniens, mais ceux-ci sont parmi les plus courants.
Le type de dépôt filonien qui se forme dépend de divers facteurs, notamment la composition et l’origine des fluides, la roche hôte et les processus géologiques à l’œuvre dans la région.
Les gisements aurifères métamorphiques sont un type de gisement minéral qui se forme à la suite du métamorphisme, qui est le processus par lequel les roches sont altérées en raison des changements de température, de pression et d’environnement chimique.
Au cours du métamorphisme, les roches préexistantes subissent un processus de recristallisation et de nouveaux minéraux peuvent se développer en réponse aux changements de leur environnement.
Les gisements métamorphiques peuvent contenir une large gamme de minéraux, y compris des métaux précieux et de base, et peuvent se trouver dans une variété de types de roches, tels que les schistes, les gneiss et les marbres.
Quelques exemples de gisements métamorphiques économiquement importants comprennent les gisements de plomb-zinc dans le Tri-State Mining District aux États-Unis, les gisements de cuivre-or de la mine Olympic Dam en Australie et les gisements d’éléments du groupe du platine du Bushveld Igneous Complex en Australie. Afrique du Sud.
Les gisements métamorphiques peuvent être classés en deux types :
- Ceux formés par le métamorphisme de gisements minéraux préexistants : comprend les gisements minéraux métamorphisés tels que les gisements de plomb-zinc, qui peuvent être transformés en gneiss ou en schistes riches en plomb-zinc par métamorphisme régional.
- Ceux formés par le métamorphisme de roches préexistantes qui ne contiennent que de faibles niveaux de minéralisation : comprend les roches sédimentaires métamorphisées, telles que le marbre, le quartzite et l’ardoise, qui peuvent être minéralisées au cours du processus métamorphique.
Il existe également certains types de dépôts métamorphiques qui sont propres à des types spécifiques de métamorphisme, tels que les dépôts de skarn qui se forment lors du métamorphisme de contact, et certains types de dépôts d’oxyde de fer-cuivre-or qui se forment lors du métamorphisme hydrothermal.– Source : GeologyScience.com
Les gisements aurifères de types skarn

Les dépôts aurifères de type skarn :
- Les gisements de skarn sont un type de gisement de minerai formé par remplacement métasomatique dans des roches carbonatées, généralement du calcaire ou de la dolomite.
- Ils se caractérisent par leur association avec le skarn, une roche métamorphique à grains grossiers et riche en silicate formée par l’interaction de fluides magmatiques chauds avec des roches carbonatées.
- Les gisements de skarn se trouvent souvent dans les zones de contact entre les roches ignées intrusives, telles que les granites, et les roches carbonatées.
- Ils peuvent également se former dans d’autres contextes où les roches carbonatées entrent en contact avec des fluides chauds riches en métaux, comme autour de failles ou dans des systèmes hydrothermaux.
- Les gisements de Skarn ont été historiquement importants en tant que source de cuivre, de fer et d’autres métaux. Ils ont été reconnus pour la première fois comme un type de gisement minéral important à la fin du 19e siècle en Europe et ont depuis été trouvés dans de nombreuses régions du monde.
- Aujourd’hui, les gisements de skarn restent une source importante de métaux et sont souvent associés à des opérations minières à grande échelle. Il existe de nombreux gisements de skarn dans le monde, dont certains sont des sources importantes de minéraux.
Voici quelques exemples de gisements aurifères miniers de type skarn :
- Mine de Bingham Canyon, États-Unis : Il s’agit de l’une des plus grandes mines de cuivre à ciel ouvert au monde, située dans l’Utah, aux États-Unis. Il s’agit principalement d’un gisement de porphyre de cuivre-or-molybdène, mais comprend également une minéralisation de skarn avec d’importantes réserves de tungstène.
- Mine d’Antamina, Pérou : Il s’agit d’un important gisement de skarn de cuivre-zinc-argent-or situé dans les Andes au Pérou. C’est l’un des plus grands producteurs de cuivre et de zinc au monde.
- Mine de Yerington, États-Unis : Il s’agit d’un gisement de skarn de cuivre et d’or situé dans le Nevada, aux États-Unis. C’était historiquement une source importante de cuivre, mais elle est inactive depuis plusieurs décennies.
- Tungsten Queen Mine, États-Unis : Il s’agit d’un gisement historique de skarn de tungstène situé en Caroline du Nord, aux États-Unis. C’était une source importante de tungstène pendant la Seconde Guerre mondiale.
- Mine de Mittersill, Autriche : Il s’agit d’un gisement de skarn de tungstène situé dans les Alpes autrichiennes. C’est l’un des plus grands gisements de tungstène au monde.
- Mine de Daheishan, Chine : Il s’agit d’un important gisement de skarn de fer et de cuivre situé dans la province du Liaoning, en Chine. C’est l’un des plus grands gisements de fer de Chine.
- Mine de Bayan Obo, Chine : Il s’agit d’un important gisement de skarn de fer-REE-fluorite situé en Mongolie intérieure, en Chine. C’est le plus grand gisement d’ETR au monde.
- Renison Bell Mine, Australie : Il s’agit d’un gisement de skarn d’étain situé en Tasmanie, en Australie. C’est l’un des plus grands gisements d’étain au monde.
- Mine El Teniente, Chili : Il s’agit d’un important gisement de skarn de cuivre situé dans la cordillère des Andes au Chili. C’est l’une des plus grandes mines de cuivre au monde.
Ce ne sont là que quelques exemples des nombreux gisements de skarn découverts dans le monde. – Source : GeologyScience.com
Les gisements aurifères de types magmatiques

Les gisements aurifères magmatiques sont des gisements minéraux associés à des roches ignées, telles que le granit, le gabbro et le basalte.
- Ils sont formés par le refroidissement et la cristallisation du magma ou de la lave, ce qui peut entraîner la concentration de divers minéraux dans la roche solidifiée.
- Les dépôts magmatiques peuvent être subdivisés en deux types principaux : intrusif et extrusif. Les dépôts magmatiques intrusifs, également appelés dépôts plutoniques, se forment lorsque le magma se solidifie dans la croûte terrestre.
- Au fur et à mesure que le magma se refroidit, les minéraux commencent à se cristalliser à partir de la fonte et se concentrent dans certaines parties de la roche.
- Les gisements qui en résultent peuvent être de taille massive et contenir de fortes concentrations de minéraux précieux, tels que le cuivre, le nickel, le platine et l’or.
- Les dépôts magmatiques extrusifs, également appelés dépôts volcaniques, se forment lorsque le magma ou la lave éclate à la surface de la Terre et se solidifie.
- Ces dépôts peuvent être trouvés sous la forme de coulées de lave, de cendres volcaniques et d’autres roches volcaniques.
- Quelques exemples de gisements magmatiques extrusifs comprennent des gisements de sulfures massifs, riches en cuivre, zinc et plomb, et des gisements d’éléments du groupe du platine, riches en platine, palladium et rhodium.
- Les gisements magmatiques peuvent être des sources économiquement importantes de divers métaux et minéraux, et ils sont souvent la cible d’activités minières et d’exploration.
- Les dépôts magmatiques sont formés à partir de magma, qui est une roche en fusion provenant du manteau terrestre ou de la croûte inférieure.
- Au fur et à mesure que le magma se refroidit et se solidifie, il peut concentrer certains éléments, qui peuvent former des gisements de minéraux précieux.
Il existe plusieurs types de gisements magmatiques, notamment :
- Gisements de porphyre : Il s’agit du type de gisement magmatique le plus courant et on les trouve généralement dans les exploitations minières de cuivre et d’or. Les dépôts de porphyre se forment lorsque le magma pénètre dans la croûte terrestre, et les minéraux se déposent lorsque le magma se refroidit et se solidifie. Les gisements de porphyre sont généralement des opérations à faible teneur mais à fort tonnage qui nécessitent des quantités importantes de traitement.
- Dépôts de Skarn: Les dépôts de Skarn sont formés par l’interaction du magma avec des roches carbonatées. La chaleur et les fluides du magma altèrent les roches carbonatées, créant une zone de minéralisation appelée skarn. Les gisements de Skarn sont connus pour leurs gisements à haute teneur de cuivre, d’or, d’argent et de tungstène.
- Gisements de pegmatite : Ces gisements sont connus pour leur nature à gros grains, ce qui les rend plus faciles à exploiter. Les pegmatites sont formées à partir du refroidissement tardif du magma et contiennent une variété de minéraux, notamment des éléments de terres rares, du lithium et du tantale. Les gisements de pegmatite sont généralement petits, mais la forte concentration de minéraux précieux peut les rendre économiquement viables.
- Gisements de kimberlite : Les gisements de kimberlite sont formés à partir de l’éruption de magma de source profonde et sont connus pour leur nature diamantifère. Les éruptions volcaniques ramènent les diamants à la surface, où ils peuvent être extraits. Cependant, les gisements de diamants dans la kimberlite sont généralement petits et sporadiques, ce qui rend les opérations minières difficiles et coûteuses.
- Dépôts de carbonatite : ces dépôts sont formés par le refroidissement et la solidification du magma de carbonatite. Les gisements de carbonatite sont connus pour leurs gisements d’éléments de terres rares et sont généralement exploités pour ces éléments, qui sont utilisés dans des applications de haute technologie.
Chacun de ces gisements magmatiques a ses propres caractéristiques uniques et leur viabilité économique dépend de divers facteurs, notamment la teneur et le tonnage du gisement, l’accessibilité du gisement et la demande du marché pour les minéraux contenus dans le gisement. – Source : GeologyScience.com
Les dépôts aurifères sédimentaires ou gisements aurifères secondaires

Les dépôts aurifères sédimentaires ou gisements aurifères secondaires sont des dépôts minéraux qui se forment par l’accumulation de sédiments sur ou près de la surface de la Terre. Ils peuvent avoir été déplacés et remaniés plusieurs fois, au fil des temps géologiques.
Ces gisements secondiares peuvent contenir une variété de minéraux, notamment des minerais métalliques, du charbon et des minéraux industriels tels que le calcaire, le sel et le gypse.
Les dépôts sédimentaires sont formés par un certain nombre de processus différents et peuvent être classés en plusieurs grandes catégories en fonction de leur minéralogie et de leur environnement de dépôt.

a) Phase de minéralisation aurifière primaire : Régime tectonique de compression, minéralisation aurifère associée à des veines de cisaillement et d’extension (shear zone), circulation de fluide hydrothermal apportant les particules et des solutions aqueuses aurifères vers la surface. L’or est disséminé dans les gisements aurifères primaires, dans les roches in situ, il sera libéré dans la nature grâce à l’érosion et au weathering.
b) Phase de concentration des placiers aurifères : Par gravité les particules d’or s’accumulent dans un dépôt aurifère au fil du temps, les conglomérats aurifères sont aussi érodés et l’or et libéré pour s’accumuler dans ce dépôt. L’érosion et le weathering sont perpétuels et libèrent de l’or depuis le gisement aurifère primaire.
c) Incision fluviale et phase de minéralisation d’or secondaire : La rivière traverse ce dépôt aurifère et charrie, déplace des particules d’or à d’autres endroits, parfois sur des longues distances. Les conditions oxydation/réduction (redox) fluctuantes permettent la solubilisation et la déstabilisation des complexes aurifères. Il voyage alors par les actions mécaniques de l’eau (pluies, intempéries, rivière), sous la forme de particules d’or ou solutions chimiques aqueuse, pour être précipité en un autre endroit.
Certains types courants de dépôts sédimentaires comprennent :
- Dépôts de placers : ces dépôts se forment lorsque des minéraux lourds sont transportés et déposés par l’eau courante ou les glaciers. Les minéraux précieux sont souvent concentrés dans les lits des cours d’eau ou sur les plages et comprennent l’or, l’étain et les diamants.
- Formations de fer (formations ferrifères rubanés ou BIF Banded Iron Formation) : ces dépôts se trouvent généralement dans des roches sédimentaires âgées de plus de 2,5 milliards d’années et sont constitués de couches alternées d’oxydes de fer et de silice ou de chert. Le fer de ces formations a été initialement déposé dans l’océan par des fluides hydrothermaux et a ensuite été concentré par une variété de processus chimiques et biologiques.
- Dépôts d’évaporite : Ces dépôts se forment lorsque l’eau saline s’évapore et laisse derrière elle une couche de sel ou d’autres minéraux d’évaporite. Les minéraux d’évaporite courants comprennent l’halite (sel gemme), le gypse et l’anhydrite. Ces gisements se trouvent généralement dans des environnements arides ou semi-arides.
- Gisements de charbon : Ces gisements se forment à partir de l’accumulation de matériel végétal dans des milieux marécageux. Au fil du temps, le matériel végétal est enterré et subit une variété de changements chimiques et physiques qui aboutissent éventuellement à la formation de charbon.
- Dépôts de phosphate : Ces dépôts se forment par l’accumulation de sédiments riches en phosphate dans les milieux marins. Les phosphates sont souvent dérivés des coquilles d’organismes marins et peuvent être extraits pour être utilisés dans les engrais et d’autres applications industrielles.
- Dépôts carbonatés : Ces dépôts se forment à partir de l’accumulation de sédiments riches en carbonates dans des milieux marins ou lacustres (lacs). Les minéraux carbonatés courants comprennent le calcaire et la dolomite. – Source : GeologyScience.com
Dépôts aurifères de types sulfures massifs volcanogènes (VMS)

Dépôts aurifères de sulfures massifs volcanogènes (VMS). Les gisements de sulfures massifs volcanogènes (VMS) sont un type de gisement minéral qui se forme sur ou sous le fond marin à la suite d’une activité volcanique et hydrothermale.
- Ils sont généralement composés de minéraux sulfurés métalliques tels que le cuivre, le zinc, le plomb, l’or et l’argent, et peuvent également contenir des quantités importantes de fer, de soufre et d’autres éléments.
- Les gisements de VMS sont généralement de taille petite à moyenne et se présentent en amas ou en ceintures, souvent en association avec des roches volcaniques sous-marines et des évents hydrothermaux.
- Les gisements de VMS sont des sources importantes de métaux de base et précieux et sont exploités depuis des milliers d’années.
- On les trouve dans les fonds marins modernes et anciens et ils sont généralement associés aux dorsales médio-océaniques, aux arcs insulaires et aux bassins d’arrière-arc.
- Certains des gisements de VMS les plus importants se trouvent au Canada, en Australie, en Scandinavie et dans la péninsule ibérique. Les gisements de sulfures massifs volcanogènes (VMS) se forment en association avec l’activité volcanique sous-marine, généralement situés le long des marges des plaques tectoniques dans les zones d’activité volcanique et/ou sismique.
- Les gisements sont généralement associés à d’anciens arcs insulaires ou à des bassins d’arrière-arc, où le fond marin a été modifié par le volcanisme lié à la subduction. Les gisements de SMV sont généralement encaissés dans des roches volcaniques et sédimentaires, y compris des roches volcaniques basaltiques à andésitiques, des roches volcaniques rhyolitiques et des roches sédimentaires marines.
- On les trouve couramment dans les ceintures de roches vertes, qui sont des terranes géologiques contenant une variété de roches volcaniques et sédimentaires, et sont associées à d’anciens arcs volcaniques.
- Le cadre géologique des gisements de VMS est caractérisé par la présence d’évents hydrothermaux ou de « fumeurs noirs » sur le fond marin, qui libèrent des fluides chauds et riches en métaux dans l’océan.
- Ces fluides réagissent avec l’eau de mer et avec les roches environnantes, déposant des minéraux dans et autour des évents. Les gisements peuvent se présenter en grappes ou en « champs » le long des chaînes volcaniques sous-marines et peuvent être associés à d’autres types de gisements minéraux, tels que les sulfures massifs du fond marin (SMS) et les gisements exhalatifs sous-marins.
Ci-dessous : des exemples de fumeurs noirs, dans les monts hydrothermaux, dans les dorsales des fonds océaniques. Ils génèrent et libèrent en permanence des métaux sous la forme de sulfures et d’oxydes métalliques. Notamment grâce aux activités microbiennes et bactériennes, par la précipitation physico-chimique, et par les variations de PH et de température. – Source : Wikipédia.


Il existe plusieurs types de gisements de SMV (sulfures massifs volcanogènes), qui sont classés en fonction de leur contexte géologique et de leur minéralogie. Voici quelques-uns des types courants :
- Gisements bimodaux de SMV : Ces gisements se forment dans des environnements volcaniques caractérisés par la présence de roches mafiques et felsiques. Les roches mafiques sont généralement basaltiques et les roches felsiques sont généralement rhyolitiques ou dacitiques.
- Gisements de SMV felsiques : Ces gisements se forment dans des environnements volcaniques dominés par des roches felsiques, comme la rhyolite et la dacite.
- Dépôts mafiques de SMV : Ces dépôts se forment dans des environnements volcaniques dominés par des roches mafiques, comme le basalte.
- Dépôts de VMS sédimentaires exhalatifs (SEDEX) : Ces dépôts se forment dans des bassins sédimentaires et sont associés à la décharge de fluides hydrothermaux à travers les roches sédimentaires.
- Gisements de type SMV de Chypre : Ces gisements portent le nom des gisements de sulfures massifs de Chypre, qui se forment dans des environnements volcaniques sous-marins et sont associés à des ophiolites (segments de croûte océanique).
- Gisements VMS de type Kuroko : Ces gisements portent le nom des gisements de sulfures massifs de la mine japonaise de Kuroko, qui se forment dans des environnements volcaniques sous-marins et se caractérisent par leur teneur élevée en zinc, plomb et cuivre.
- Gisements SMV de type Algoma : Ces gisements portent le nom des gisements de sulfures massifs du district canadien d’Algoma, qui se forment dans des environnements volcaniques sous-marins et se caractérisent par leur teneur élevée en cuivre.
Chaque type de gisement de SMV a ses propres caractéristiques uniques en termes de cadre géologique, de minéralogie et d’importance économique.
Les gisements de sulfures massifs volcanogènes (SMV) se forment à partir de fluides hydrothermaux issus de l’activité volcanique.
Les fluides sont riches en soufre et en métaux, et ils sont souvent expulsés des évents volcaniques sur le fond marin. Lorsque les fluides chauds rencontrent de l’eau de mer froide, ils se refroidissent rapidement, provoquant la précipitation des métaux et du soufre et la formation de dépôts minéraux.
La minéralogie des gisements de VMS est complexe, avec de nombreux minéraux différents présents. Les gisements sont généralement constitués de couches de sulfures métalliques, tels que la chalcopyrite, la sphalérite et la galène, mélangées à des minéraux de la gangue tels que la pyrite, le quartz et le feldspath.
Les gisements peuvent également contenir des quantités importantes d’or et d’argent, ainsi que des quantités mineures d’autres métaux tels que le cobalt, le nickel et l’étain.
La minéralogie des gisements de VMS peut varier en fonction du contexte géologique spécifique dans lequel ils se forment. – Source : GeologyScience.com
Gisements aurifères de types hydrothermaux

Les dépôts aurifères de types hydrothermaux :
- Les gisements hydrothermaux sont des gisements minéraux qui se forment à partir de la précipitation de minéraux dissous dans l’eau chaude qui circule à travers les roches.
- Les fluides hydrothermaux sont généralement des solutions aqueuses chaudes et hautement minéralisées qui sont créées par l’interaction des eaux souterraines avec des sources de chaleur profondes.
- Les fluides sont souvent entraînés par l’activité volcanique, comme les intrusions magmatiques ou les évents volcaniques. En circulant à travers les roches hôtes, les fluides hydrothermaux peuvent dissoudre et transporter une grande variété de minéraux.
- Lorsque ces fluides refroidissent et que les minéraux qu’ils contiennent deviennent sursaturés, ils peuvent précipiter hors de la solution et former des dépôts minéraux.
- Les gisements hydrothermaux peuvent se former dans une variété de contextes géologiques, y compris les veines, les brèches et les corps de remplacement.
- Ils peuvent également se produire dans une gamme de roches hôtes différentes, y compris des roches ignées, métamorphiques et sédimentaires.
- Le type et la distribution des minéraux que l’on trouve dans les gisements hydrothermaux dépendent de la composition des fluides hydrothermaux, des conditions de température et de pression dans lesquelles les fluides ont circulé et de la nature des roches hôtes.
Il existe de nombreux types de gisements hydrothermaux, mais certains des plus importants sont :
- Dépôts veineux : Ce sont des dépôts minéraux qui se produisent dans des fissures ou des fissures dans les roches. Ils se forment lorsque des fluides hydrothermaux circulent à travers les roches et déposent des minéraux dans les fissures. Les gisements filoniens sont souvent riches en métaux tels que l’or, l’argent, le cuivre et le plomb.
- Dépôts de skarn : Les skarns sont des roches métamorphiques de contact qui se forment lorsque des fluides hydrothermaux entrent en contact avec des roches carbonatées. Les gisements de Skarn peuvent contenir une large gamme de minéraux, notamment du cuivre, du zinc, du fer et du tungstène.
- Gisements de remplacement : Ces gisements se forment lorsque les fluides hydrothermaux remplacent les minéraux dans les roches avec lesquelles ils entrent en contact. Les gisements de remplacement sont souvent associés à du calcaire ou à d’autres roches carbonatées et peuvent contenir du plomb, du zinc et du cuivre.
- Gisements de sulfures massifs volcanogènes (VMS) : les gisements de VMS sont associés à une activité volcanique sous-marine. Ils se forment lorsque des fluides hydrothermaux chauds et riches en métaux se mélangent à de l’eau de mer froide et précipitent des sulfures métalliques. Les gisements de VMS peuvent contenir du cuivre, du zinc, du plomb, de l’or et de l’argent.
- Gisements de porphyre : Les gisements de porphyre sont de grands gisements à faible teneur qui sont souvent associés au cuivre et à l’or. Ils se forment lorsque de grands volumes de fluides hydrothermaux circulent à travers une grande surface de roche, altérant la roche et déposant des minéraux.
- Gisements épithermaux : Les gisements épithermaux se forment à faible profondeur et sont généralement associés à une minéralisation à forte ou faible sulfuration.
Ces gisements sont souvent associés à des roches volcaniques et peuvent contenir de l’or, de l’argent, du cuivre et d’autres métaux. – Source : GeologyScience.com
Pour être le plus complet possible, sur les types de gisements aurifères existant dans la nature, je vous invite à consulter cet article, intitulé Vidéos : les gisements de dépôts de minerais aurifères et métallifères dans la nature – SprottEDU, avec plusieurs vidéos (en anglais) :
L’analyse et l’observation de l’or aux multiples formes et couleurs
La fine observation systématique des grains et des paillettes d’or à l’oeil nu ou au microscope procure l’avantage d’en savoir plus sur leurs origines, histoires, parcours et genèse.
En fait tous chercheurs d’or ou prospecteurs d’or avisés, méthodiques, curieux, précis, devraient systématiquement observer les contenus des sables noirs obtenus dans les concentrés aurifères au fond de leurs pans après les lavages, et observer méticuleusement les grains et les paillettes d’or découverts durant leurs sessions de prospections aurifères, car cela représente une incroyable quantité d’informations utiles !
2 paramètres sont à prendre en compte :
- La couleur de l’or, qui est un indice important pour en établir sa pureté et sa composition d’alliage, de manière empirique,
- Les formes de l’or, qui sont des indices pour comprendre et interpréter les caractéristiques physiques, environnementales, les origines et les genèses des grains et des paillettes d’or découvertes en place au fond du pan, dans les sables noirs. Les formes observées sont la somme des actions mécaniques, physiques et chimiques que les grains et paillettes d’or ont subit durant leurs déplacements ou voyages et dans leur environnement immédiat.
Bien évidemment, cela demande des efforts supplémentaires pour les prospecteurs, car il ne suffit pas de simplement récolter l’or mais il faut trier, isoler, observer, photographier et quantifier les trouvailles et les résultats des cueillettes d’or.
Il faut faire des photographies et se constituer une base de données SIG cartographiée d’échantillons, qui a l’avantage, à long terme, de non seulement servir de bibliothèque et de journal de bord des prospections aurifères, mais surtout, de pouvoir à terme de réaliser des observations fines, des comparaisons et des statistiques.
Je vous invite donc à faire l’acquisition d’un microscope, pour non seulement découvrir un nouveau monde (l’or, les contenus des sables noirs), mais aussi pour exercer votre œil et apprendre à interpréter les formes des grains et des paillettes d’or. Vous verrez, cela est passionnant !
En parlant des sables noirs, justement, j’y viens : apprendre à identifier les minéraux et les cristaux composant les sables noirs au microscope vous permettra d’obtenir des informations très précieuses sur l’environnement géologique immédiat (à proximité ou en amont de la zone de l’échantillon), et d’apprendre à différencier les caractéristiques minéralogies de chaque rivières ou cours d’eau.
Ces informations sont aussi importantes que les formes de l’or de vos trouvailles.
Le livre de référence devenu introuvable et rare, en ce qui concerne le classement et la définitions des minéraux composant les sables noirs, c’est l’ouvrage incontournable de Pierre DEVISMES, intitulé Atlas photographique des minéraux d’alluvions, des mémoires du BRGM datant de 1978. Cela fait plusieurs années que je le recherche en version papier, pour l’acheter, mais je n’arrive pas à le trouver.
Pour le partage du savoir et de la connaissance, comme il est introuvable, et que vous le cherchez tous désespérément, voici exceptionnellement la version en PDF, cet ouvrage qui mérite particulièrement d’être republié et réédité :
Etudions maintenant les différentes couleurs de l’or :

Voici les interprétations possibles des observations des couleurs des grains et des paillettes d’or, révélant leurs alliages naturel à la surface :
- L’or jaune / reflets rouge-jaune : indice d’un or de très grande qualité, d’une grande pureté, avec un titre élevé en or Au.
- L’or rose / reflets rouge : c’est un alliage d’or qui contient au moins 70% de cuivre Cu.
- L’or jaune à reflets vert pâle : c’est un alliage d’or qui contient au moins 30 % à 50% d’argent Ag.
- L’or blanc / gris (électrum) : c’est un alliage d’or qui contient plus de 50% d’argent Ag.
NB. Les teneurs des alliages ne sont pas uniformes et varient au sein d’une paillette ou grain d’or, entre la surface et le coeur.
Ci-dessous : 2 beaux grains d’or, de bonnes tailles, des spécimens découverts dans les montagnes de Pyrénées, en Ariège. Il est toujours très agréable pour un prospecteur de découvrir de l’or de cette taille. Ils ont été trouvés en dessous un très gros bloc de pierre de 1 m de diamètre. Cela est le fruit de beaucoup de travaux et de recherches sur le terrain, de tâtonnements et d’échecs.


Ci-dessous : Un autre magnifique spécimen de grain d’or découvert dans les Pyrénées, dans le Sud Ouest de la France, avec ces frères et soeurs. Il est doté d’une patine superficielle d’oxyde de fer, de couleur rouille. De par sa boursouflure irrégulière, ce grain d’or a très probablement été formé en place, à partir d’un nucléus, et il a grossit au fil du temps. Certaines rivières sont de véritables nurseries à bébé or, dont les nano-particules vont grossir petit à petit à cause des apports ioniques en solutions aqueuse, aux agents catalyseurs de la précipitation de l’or ou bien grâce aux travaux des micro-organismes présents dans le substrat. Le Fer est un élément métallique qui joue le rôle de catalyseur de précipitation de l’or.



Ci-dessous: des paillettes et des grains d’or de différentes formes, aspects et couleurs, toutes en provenance d’un gisement d’or secondaire détritique. La diversité de l’or dans la nature est incroyable! Leurs origines, provenances et histoires sont variées. L’étude et l’interprétation des formes des grains et de paillettes d’or est une discipline très importante pour tout prospecteur sérieux car ce sont des sources d’informations complémentaires et très utiles !
























Ces structures et formes sont des photographies instantanées de la somme des influences bio-géochimiques, mécaniques et physiques sur l’or, au cours de sa formation, de son voyage et des actions mécaniques de la rivière dans son environnement immédiat.
Ci-dessous: des vues détaillées prises au microscope optique binoculaire, et montrant les surfaces et les formes de grains ou de paillettes d’or en provenance de gisements secondaires aurifères. Notez dans la photo de droite, en haut, la présence d’un grain d’or blanc/gris, qui est en fait de l’électrum, un alliage naturel d’or et d’argent. Il a été formé à partir de particules d’or et d’agent, en provenance d’un gisement métallifère sulfuré, riche en pyrites, chalcopyrite, blende et en galène argentifère (minerais de plomb argentifère). En fait, ce que nous observons ici, c’est du bébé or qui va grossir dans le cours d’eau, par l’action des bactéries et des micro-organismes.


En général, les gisements primaires d’or sont souvent associés à des minéraux de quartz et de sulfure métalliques (pyrite, chalcopyrite, blende, galène, arsenopyrite…), formés dans des environnements à haute pression et température profondément sous la surface de la Terre.
Lorsque les sources primaires sont soumises à un soulèvement et / ou à une altération physique (par exemple, processus éluviaux, colluviaux ou (glacio) fluviaux), des dépôts secondaires d’or (c’est-à-dire des placers) peuvent éventuellement se former.
Ci-dessous: quelques beaux grains d’or, découverts au fond du pan, après lavage de substrats aurifères, et après concentration des particules lourdes (sables noirs). Les actions mécaniques de l’eau, des graviers et des galets font façonner les formes des paillettes et des grains d’or, au fil du temps, et vont tendre à les plier, les aplatir, et les émousser.



Pendant l’altération, l’or est libéré de la roche primaire et se présente souvent sous forme de particules plus pures et raffinées de différentes tailles, également appelées pépites d’or, grains d’or, paillettes d’or et farine d’or.
Les bactéries et les archées sont considérées comme les formes de vie les plus simples capables de métabolisme. Ils existent depuis des milliards d’années et sont omniprésents dans la nature, aussi bien en surface, que dans les sols.
Les microbes actifs développant ces métabolismes sont capables de modifier la géochimie de leur environnement immédiat, par exemple, en catalysant des réactions redox et en s’adaptant à des conditions qui seraient considérées comme extrêmes par d’autres formes de vie.
Les processus de dissolution et de précipitation de l’or sont souvent liés au cycle d’autres éléments, tels que le carbone, le fer et le soufre.
Les bactéries influencent directement la solubilisation de l’or, la formation de nanoparticules d’or, l’agrégation des nanoparticules et la re-distribution de l’or dans l’environnement naturel.
Ces considérations nous donnent l’occasion de constater la mobilité de l’or et comment il peut être déplacé dans des conditions environnementales proches de la surface.
Les micro-organismes capables de solubiliser et de précipiter activement l’or semblent jouer un rôle plus important dans le cycle bio-géochimique de l’or qu’on ne le croyait auparavant ; ces dernières années de nombreuses recherches scientifiques ont été effectuées confirmant ces idées.
Les bactéries et les archées sont impliquées dans chaque étape du cycle biogéochimique de l’or, de la formation de la minéralisation primaire dans les systèmes hydrothermaux et souterrains profonds, à sa solubilisation, dispersion et re-concentration en or secondaire plus pur dans des placiers.
Les caractéristiques géochimiques de l’or
Dans ce chapitre, je vais vous présenter les règles principales des réactions chimiques de solubilisation de l’or en solution aqueuse dans la nature, qui permettent sa grande mobilité.
Bien que pas forcément chimiste né, tout bon prospecteur devrait essayer de bien comprendre et d’assimiler certaines de ces notions que je vais tenter de vous simplifier pour une meilleure compréhension de tous, au sens large du terme.
Ce sujet pouvant être ardu et complexe, sa vulgarisation et sa simplification a été pour moi une tâche aussi difficile qu’essentielle.
Comme nous allons le voir ci-dessous, il est judicieux de considérer que les rôles de la Vie et de la Biologie des organismes vivants, notamment celui du monde végétal et des microbes sont étroitement liés au Cycle de l’or.
Le dépôt d’or dans les gisements primaires se produit généralement via des fluides hydrothermaux riches en métaux, remontant en permanence des profondeurs de la croute terrestre et du manteau, qui circulent vers la surface via des espaces ouverts à l’intérieur des roches (failles, interstices,…) et y déposent de l’or grâce au refroidissement ou à l’ébullition, ou bien par des phénomènes de précipitations ou de cristallisations.
Dans ces fluides hydrothermaux, l’or est chimiquement mobile sous forme de complexes chimiques aqueux ou solubilisés, avec les sulfures et les bisulfures (par exemple, [Au (HS) 0], [Au (HS2) ], [Au2S2 ]), qui servent de vecteurs à la mobilisation chimique de l’or parfois sur de très longues distances (se sont des véhicules, des taxis chimiques ou des transporteurs d’or moléculaire).
Les variations de température, de pression, de pH, de EC, d’environnement chimiques en un endroit précis vont finalement avoir pour conséquence, lorsque les conditions sont réunies :
- de cristalliser l’or,
- solidifier l’or,
- et de faire précipiter les métaux et l’or,
- soit sous une forme native, ou oxydée, ou sulfurée, ou sous d’autres formes de composés chimiques divers et variés.
Par exemple, les dépôts métallifères à partir de ces solutions aqueuses conduisent la formation de minéraux et de minerais sulfurés métallifères contenant de l’or, de l’argent, du cuivre, du zinc, et du plomb :
- la pyrite (FeS2),
- la chalcopyrite (CuFeS2),
- l’arsénopyrite (FeAsS),
- la galène (PbS),
- la blende ou sphalérite (ZnS) .
dans lesquels l’or est soit finement dispersé et disséminé dans des réseaux cristallins, soit il se présente sous forme d’inclusions solides plus ou moins visibles, ou sous la forme de nanoparticules d’or.
Cette liste n’est pas complète, il y a d’autres sulfures métallifères existants dans la nature.
La plupart des gisements métallifères sulfurés contiennent de l’or, dans les proportions variables (<1 gramme à quelques dizaines de grammes à la tonne).






En outre, si l’on souhaite être complet, il en est de même pour les dépôts aurifères dans les veines de quartz : ce sont ces mêmes variations de température, de pression, de pH et d’environnements chimiques qui vont faire cristalliser et figer les quartz dans les veines et l’ensemble des métaux présent intrinsèquement, soit sous des formes natives, disséminées ou bien dans divers complexes minéraux à teneurs variables.


Le weathering et l’érosion, entrainent la mobilité chimique de l’or dans les zones supergènes (très riches en oxygène) ; c’est une conséquence liée à l’altération de ces minéraux sulfurés, et à leurs oxydation.
Dans des conditions de surface, l’or se trouve sous forme de colloïdes métalliques ou nano-particules d’or (0) et de complexes aureux (Au+) et auriques (Au 3+) en solution aqueuse.
Les complexes chimiques aqueux d’or (aureux et auriques), les thiosulfates d’or et les chlorures d’or sont les plus abondants dans les eaux contenant peu de matière organique dissoute.
Il a été démontré que :
- le thiosulfate solubilise facilement l’or, et le complexe de thiosulfate aureux résultant est stable d’un pH légèrement acide à très alcalin et modérément oxydant à des conditions réductrices ; c’est donc un excellent véhicule ou transporteur d’or.
- Le thiosulfate est produit lors de la (bio) oxydation des minéraux sulfurés et est donc susceptible d’être présent dans les eaux souterraines entourant les gisements de sulfures aurifères.
Les eaux souterraines oxydantes à haute teneur en chlorures dissous, courantes dans les zones arides et semi-arides, peuvent également solubiliser l’or, conduisant à la formation de complexes de chlorure d’or aureux et auriques ([AuCl 2] et [AuCl 4]).
Cependant, contrairement au complexe chlorure d’or aurique, le complexe chlorure d’or aureux (AuCl 2) n’est pas stable à basse température et dans des conditions oxydantes ; ces complexes chimiques restent toutefois d’excellents véhicules transporteurs d’or, temporaires et instables à prendre en considération, car ils existent dans la nature.
L’or forme également des complexes avec des ligands organiques ; une caractéristique des métaux du groupe IB est leur capacité à se lier fortement à la matière organique:
- les acides organiques,
- les acides humiques,
- les acides fulviques,
- les acides aminés,
- les acides carboxyliques,
favorisent la solubilisation de l’or natif.
L’interaction de l’or et de la matière organique implique principalement des éléments donneurs d’électrons, tels que l’azote (N), l’oxygène (O) ou le souffre (S), plutôt que carbone (C).
L’or a une grande afinité pour le soufre (S) organique dans des conditions réductrices, alors que dans des conditions oxydantes, il se lie principalement à l’azote (N) et au carbone (C), pour former des complèxes aurifères organiques.
Les complexes organiques aurifères peuvent être présents en solution aqueuse sous forme de complexes de cyanure d’or aureux, l’or forme un complexe fort avec le cyanure [Au (CN) 2] qui est stable sur une large gamme de conditions Eh-pH.
L’absorption des complexes d’or et des colloïdes aurifères vers la matière organique, les argiles, les minéraux Fe et Mn, ainsi que la bio-accumulation et la bio-minéralisation peuvent conduire à la formation de particules d’or secondaires, qui sont souvent observées à proximité des gisements primaires soumis au processus de weathering.
L’or secondaire est généralement beaucoup plus fin et pur (jusqu’à 99% en poids d’or) par rapport à l’or primaire, et les agrégats d’or individuels sont souvent plus gros que dans les roches mères potentielles. Ce phénomène se confirme par l’observation des échantillons sur le terrain.
L’or élémentaire est dérivé de sources primaires ou secondaires, créant un cycle perpétuel.
L’or peut être dissous et solubilisé en présence d’agents oxydants forts et de composés chimiques de coordination, pour former des complexes solubles aureux (Au+) ou auriques (Au3+), en solution aqueuse.
D’un point de vue géochimique, le chlorure (Cl−) et le thiosulfate (S2O32−) sont considérés comme les deux ligands de coordination les plus probables pour la solubilisation de l’or dans la nature.

Réactions chimiques de l’or avec les ions chlorures (1).
Avec les composés thiosulfates issus de l’altération oxydante des sulfures métalliques (2) (3).
Avec le cyanure par certains microbes bactéries de type cyanobactéries (4).
Source : Mechanism of Gold Bioaccumulation by filamentous cyanobacteria from Gold(III), chloride complex. Auteurs : Lengke MF, Ravel B, Fleet ME, Wanger G, Gordon RA, Southam G.
Ci-dessous, voici les explications des réactions chimiques énoncées :
Dans les environnements très riches en sel (NaCl), AuCl4− serait probablement le complexe dominant de solubilisation de l’or, puisque les ions Cl− en excès seraient disponibles comme ligand de coordination (réaction 1).
Cependant, dans les environnements où les ions Cl− sont moins abondants, les composés thiosulfates (S2O3 2−) prennent le relais, et sont considérés comme un important ligand de coordination qui forme de l’or soluble (S2O3)2 3−.
Le thiosulfate et d’autres polythionates sont produits lors de l’altération (bio) oxydante des sulfures métalliques (pyrite, blende, galène, chalcopyrite, arsenopyrite…).
Par conséquent, (S2O3 2−) est raisonnablement considéré comme un ligand de coordination incontournable, en particulier si les alliages d’or ou Or / Argent élémentaires sont étroitement associés aux minéraux primaires de sulfure de métal (exemple de la galène argentifère + pyrite), voir les réactions 2 et 3.
M représente le métal Or natif, l’élément Au.
Le cyanure (CN−), un acide inorganique naturel, peut également agir comme ligand de coordination pour former Au (CN) 2−, qui a été détecté dans les eaux des résidus miniers et des forages d’or.
Sur les sites miniers exploitant l’or, le cyanure CN− peut être dérivé de sources anthropiques (pollution) qui ont été rejetées au cours des processus de lixiviation, par exemple, le lessivage en tas de minerais aurifères.
Cependant, dans les environnements naturels, certains microbes (les cyanobactéries), sont connus pour produire naturellement du CN− en tant que sous-produit du métabolisme et il a été démontré qu’ils solubilisent l’or élémentaire, voir la réaction 4.
Enfin, des facteurs chimiques, tels que le pH ambiant, peuvent influencer la stabilité des complexes solubles d’or :
- Par exemple, Au(S2O3)2 3− est généralement plus stable dans des conditions de pH neutre, tandis que les complexes auriques Au+/chlorures sont plus stables dans des conditions acides.
- De plus, les complexes aureux Au+ sont généralement considérés comme moins stables et plus transitoires, car ils peuvent facilement se dissocier en Au élémentaire et en or aurique Au3+.
La bio-minéralisation de l’or et sa biochimie en interaction avec les bactéries
La membrane cytoplasmique des cellules bactériennes ont généralement une charge négative à la surface de l’enveloppe qui ont tendance à ioniser et à lier les métaux, et elle se comporte comme une sorte de glue ou d’aimant, elle va attirer des particules métalliques.
Cette bio-minéralisation passive engendrée par les bactéries est un mécanisme dans lequel les précipités métallifères induits peuvent nucléer et s’accumuler sur les cellules.
Dans le contexte de la bio-minéralisation de l’or, plusieurs études ont évalué les mécanismes de réduction et les capacités de divers microorganismes métabolisants et non-métabolisants, lorsqu’ils sont exposés à une variété de différents complexes d’or solubles.
L’exposition de bactéries à des complexes solubles d’or aqueux entraîne souvent la formation extracellulaire ou intracellulaire :
- de colloïdes (s’étalant du nanomètre au micromètre, c’est-à-dire des échelles telles qu’en milieu liquide, l’agitation thermique est observable),
- de cristaux nanophases (matériaux dont la granulométrie est inférieure à 100 nanomètres),
- de structures cristallines (constituées par la répétition périodique dans les 3 dimensions de l’espace d’un motif atomique ou moléculaire),
- de nanoparticules d’or (un nano-objet dont les trois dimensions sont à l’échelle nanométrique, c’est-à-dire une particule dont le diamètre nominal est inférieur à 100 nm environ),
dont les forment peuvent varier en fonction des micro-organismes.
Il est aussi important de se signaler que les métaux lourds sont souvent hautement cytotoxiques pour les bactéries et les micro-organisme.
La cytotoxicité est la propriété d’un agent chimique ou biologique à être toxique pour les cellules, pouvant éventuellement jusqu’à les détruire. Cela inclut les complexes solubles d’or.
Les métaux solubles sont capables de provoquer la lyse des cellules, libérant ainsi du matériel intracellulaire, provocant la mort de la bactérie.
En biologie, la lyse est la destruction de la membrane plasmique de cellules eucaryotes ou bactéries par action d’un agent physique, chimique ou biologique et menant à la mort de la cellule. Les produits résultants sont des lysats.
Lorsque ces matières organiques sont libérées dans l’environnement à proximité immédiate des bactéries, elles peuvent agir comme agents réducteurs supplémentaires pour la réduction du métal soluble.
La résilience des biofilms aux effets toxiques de l’or soluble a été démontrée par diverses expérimentations en laboratoire.
Un biofilm est une communauté multicellulaire plus ou moins complexe, souvent symbiotique, de micro-organismes (bactéries, microchampignons, microalgues ou protozoaires), adhérant entre eux et à une surface, et marquée par la sécrétion d’une matrice adhésive et protectrice. Il se forme généralement dans l’eau ou en milieu aqueux.
Dans un environnement aurifère, les cellules situées à l’interface biofilm/fluide sont souvent directement exposées à des solutions aqueuses contenant de l’or.
La réduction de l’or soluble par les cellules situées à la surface de contact de cette interface protège les cellules enfouies plus profondément dans le biofilm des effets toxiques de l’or solubilisé aqueux.
Nous pouvons définir le biofilm comme une sorte de carapace de protection pour les colonies de microbes ou de bactéries, qui tendent à protéger ces dernières d’agressions ou de composés toxiques en provenance de l’extérieur.
L’un des plus connu est le biofilm de la bactérie Escherichia coli, par exemple, qui est difficile à éradiquer, et vis à vis de laquelle parfois les antibiotiques peuvent avoir des actions limitées ; elle crée de nombreux décès dans le monde entier (et je sais que quoi je parle par j’ai failli moi-même en mourir intoxiqué par la bactérie – infection nosocomiale suite à une opération médicale -).
La bio-minéralisation de l’or met en évidence le potentiel de mobilité de l’or sous forme de nanoparticules, ainsi que l’accumulation de ces nanoparticules pour former des structures plus grandes et complexes, aboutissant à la formation « spontanée » de grains, paillettes et de pépites d’or, bien que cela reste mystérieux mais explicable.
Par conséquent, dans un environnement proche de la surface, la bio-minéralisation a la possibilité d’être un processus continu, tant que la croissance métabolique des microbes est soutenue.
L’ion formiate ou méthanoate, de formule HCOO−, est un anion carboxylate, la base conjuguée de l’acide méthanoïque ou acide formique (HCOOH). Le terme formiate/méthanoate désigne également les sels ou esters de cet acide carboxylique. Le formiate est un anion, c’est-à-dire un ion négatif. Il est formé d’un atome de carbone, d’un atome d’oxygène et de deux atomes d’hydrogène. L’atome de carbone est lié à l’atome d’oxygène par une double liaison et à chacun des deux atomes d’hydrogène par une liaison simple.

Le formiate joue un rôle important dans la vie microbienne.
Il est utilisé par de nombreux micro-organismes comme source d’énergie, de carbone et d’azote :
- Source d’énergie : Certains micro-organismes, comme les bactéries fermentatives, utilisent le formiate comme source d’énergie. Ils le décomposent en dioxyde de carbone et en eau, en libérant de l’énergie.
- Source de carbone : Le formiate peut également être utilisé par les micro-organismes comme source de carbone. Il est utilisé pour la synthèse de molécules organiques, telles que les acides aminés, les sucres et les lipides.
- Source d’azote : Le formiate peut également être utilisé par les micro-organismes comme source d’azote. Il est utilisé pour la synthèse d’acides aminés contenant de l’azote, tels que la glutamine et la proline.
- Autres rôles : Le formiate joue également d’autres rôles dans la vie microbienne. Il peut être utilisé par les micro-organismes pour la synthèse de composés biochimiques, tels que les hormones et les antibiotiques. Il peut également être utilisé par les micro-organismes pour la protection contre les agents pathogènes.
Voici quelques exemples du rôle du formiate dans la vie microbienne :
- Les bactéries fermentatives du genre Lactobacillus utilisent le formiate pour produire du fromage et du yaourt.
- Les bactéries du genre Acetobacter utilisent le formiate pour produire du vinaigre.
- Les bactéries du genre Clostridium utilisent le formiate pour produire du gaz naturel.
- Les bactéries du genre Pseudomonas utilisent le formiate pour produire des antibiotiques.
Le formiate est donc un composé primordial pour la vie microbienne.
Il joue un rôle dans de nombreux processus biologiques, notamment la production d’énergie, la synthèse de molécules organiques et la protection contre les agents pathogènes.
D’après plusieurs études scientifiques sérieuses, il a été démontré que les microbes qui sont capables d’oxydation / réduction du fer ou du soufre sont considérés comme les plus propices à la bio-minéralisation de l’or.
En outre, certains microbes métallophytes sont résistants aux métaux, tels que représentés par la réaction 10.

Ci-dessous, les explications détaillées et complètes des réactions et formules chimiques énoncées, pour une meilleure compréhension :
Réaction 6 : représente une réaction chimique entre des ions fer(III) (Fe3+) dissous dans l’eau (aq), des ions thiosulfate (S2O3)2- dissous dans l’eau (aq) et de l’eau (H2O) pour former des ions or(I) (Au+) dissous dans l’eau (aq), des ions thiosulfate (S2O3)2- dissous dans l’eau (aq), des ions sulfate (SO42-) dissous dans l’eau (aq) et des ions hydrogène (H+) dissous dans l’eau (aq).
Explication des symboles chimiques
- Fe représente le fer.
- 3+ représente une charge positive.
- (aq) représente un composé dissous dans l’eau.
- Au représente l’or.
- (S2O3) représente le thiosulfate.
- 2- représente une charge négative.
- (3-) représente une charge négative.
- H représente l’hydrogène.
- + représente une charge positive.
Explication de la réaction chimique
- Dans cette réaction chimique, les ions fer(III) (Fe3+) perdent deux électrons à l’ion or(I) (Au+).
- Les ions fer(III) (Fe3+) deviennent alors des ions fer(II) (Fe2+).
- L’ion or(I) (Au+) gagne deux électrons pour devenir un atome d’or pur (Au0).
- Les ions thiosulfate (S2O3)2- sont également impliqués dans la réaction. Ils jouent le rôle d’intermédiaires.
- Ils acceptent quatre électrons des ions fer(III) (Fe3+) et les transfèrent à l’ion or(I) (Au+).
- L’eau (H2O) est également impliquée dans la réaction.
- Elle fournit les deux électrons perdus par les ions fer(III) (Fe3+) et les deux électrons gagnés par l’ion or(I) (Au+).
Explication des changements d’état
Les ions fer(III) (Fe3+) et les ions thiosulfate (S2O3)2- sont dissous dans l’eau (aq) au début de la réaction. À la fin de la réaction, les ions fer(II) (Fe2+) sont dissous dans l’eau (aq), les ions thiosulfate (S2O3)2- sont dissous dans l’eau (aq), les ions sulfate (SO42-) sont dissous dans l’eau (aq) et les ions hydrogène (H+) sont dissous dans l’eau (aq).
Réaction 7 : représente une réaction chimique entre des ions thiosulfate (S2O3 2-) dissous dans l’eau (aq), de l’eau (H2O) et des ions hydrogène (H+) pour former de l’acide sulfurique (H2SO4) et des ions hydrogène sulfuré (HS-).
Explication des symboles chimiques
- S représente le soufre.
- 2O3 représente le thiosulfate.
- 2- représente une charge négative.
- H représente l’hydrogène.
- H2O représente l’eau.
- aq représente un composé dissous dans l’eau.
- + représente une charge positive.
Explication de la réaction chimique
- Dans cette réaction chimique, les ions thiosulfate (S2O3 2-) oxydant les ions hydrogène (H+) pour former de l’acide sulfurique (H2SO4). Dans le processus, le soufre dans l’ion thiosulfate est réduit au soufre dans l’ion hydrogène sulfuré (HS-).
- L’eau (H2O) agit comme un catalyseur pour la réaction, ce qui signifie qu’elle accélère la réaction mais n’est pas consommée dans le processus.
Explication des changements d’état
Les ions thiosulfate (S2O3 2-) et les ions hydrogène (H+) sont dissous dans l’eau (aq) au début de la réaction. À la fin de la réaction, l’acide sulfurique (H2SO4) et les ions hydrogène sulfuré (HS-) sont dissous dans l’eau (aq).
Réaction 8 : représente une réaction chimique entre des ions or(I) (Au+) dissous dans l’eau (aq), des ions hydrogène sulfuré (HS-) dissous dans l’eau (aq) pour former du sulfure d’or(I) (Au2S) solide et des ions hydrogène (H+) dissous dans l’eau (aq).
Explication des symboles chimiques
- Au représente l’or.
- + représente une charge positive.
- H représente l’hydrogène.
- S représente le soufre.
- – représente une charge négative.
- aq représente un composé dissous dans l’eau.
Explication de la réaction chimique
Dans cette réaction chimique, les ions or(I) (Au+) perdent deux électrons aux ions hydrogène sulfuré (HS-). Les ions or(I) (Au+) deviennent alors des atomes d’or pur (Au0). Les ions hydrogène sulfuré (HS-) gagnent deux électrons pour devenir des ions hydrogène (H+).
Le sulfure d’or(I) (Au2S) est un solide insoluble dans l’eau. Il se forme à la fin de la réaction, lorsque les ions or(I) (Au+) et les ions hydrogène sulfuré (HS-) s’unissent. Les ions hydrogène (H+) sont dissous dans l’eau à la fois au début et à la fin de la réaction.
Cette réaction chimique est utilisée dans l’extraction de l’or. Elle permet de séparer l’or des autres métaux qui se trouvent avec lui dans la roche.
Réaction 9 : représente une réaction chimique entre des ions or(I) (Au+) dissous dans l’eau (aq), des ions fer(II) (Fe2+) dissous ou solides dans l’eau (aq/s) pour former de l’or pur (Au0) solide et des ions fer(II) (Fe2+) dissous dans l’eau (aq).
Explication des symboles chimiques
- Au représente l’or.
- + représente une charge positive.
- H représente l’hydrogène.
- S représente le soufre.
- – représente une charge négative.
- aq représente un composé dissous dans l’eau.
- s représente un composé solide.
Explication de la réaction chimique
- Dans cette réaction chimique, les ions or(I) (Au+) perdent un électron aux ions fer(II) (Fe2+).
- Les ions or(I) (Au+) deviennent alors des atomes d’or pur (Au0).
- Les ions fer(II) (Fe2+) gagnent un électron pour devenir des ions fer(III) (Fe3+).
- L’or pur (Au0) est un solide insoluble dans l’eau.
- Les ions fer(II) (Fe2+) sont dissous dans l’eau à la fois au début et à la fin de la réaction.
- Dans cette réaction chimique, les ions fer(II) (Fe2+) peuvent être dissous ou solides dans l’eau.
- Si les ions fer(II) (Fe2+) sont dissous dans l’eau, la réaction se déroule comme indiqué ci-dessus.
- Si les ions fer(II) (Fe2+) sont solides dans l’eau, la réaction se déroule de la même manière, mais les ions fer(II) (Fe2+) sont convertis en ions fer(III) (Fe3+) solides.
Réaction 10 : représente une réaction chimique entre l’acide aurichlorohydrique (HAuCl4) dissous dans l’eau (aq), le sulfure de fer(II) (FeS) solide pour former de l’or pur (Au0) solide, des ions fer(III) (Fe3+) dissous dans l’eau (aq), du soufre (S) dissous dans l’eau (aq), des ions chlorure (Cl-) dissous dans l’eau (aq) et de l’acide chlorhydrique (HCl) dissous dans l’eau (aq).
Explication des symboles chimiques
- Au représente l’or.
- H représente l’hydrogène.
- Cl représente le chlore.
- S représente le soufre.
- – représente une charge négative.
- (aq) représente un composé dissous dans l’eau.
- (s) représente un composé solide.
Explication de la réaction chimique
- Dans cette réaction chimique, les ions chlorure (Cl-) de l’acide aurichlorohydrique (HAuCl4) dissous dans l’eau (aq) réagissent avec les atomes de fer (Fe) du sulfure de fer(II) (FeS) solide pour former des ions fer(III) (Fe3+) dissous dans l’eau (aq) et du soufre (S) dissous dans l’eau (aq).
- L’or (Au) est libéré de l’acide aurichlorohydrique (HAuCl4) et se forme sous forme d’or pur (Au0) solide.
- L’acide chlorhydrique (HCl) est formé par l’association des ions chlorure (Cl-) et des ions hydrogène (H+) libérés par l’acide aurichlorohydrique (HAuCl4) et le sulfure de fer(II) (FeS).
- L’or (Au) est libéré de l’acide aurichlorohydrique (HAuCl4) et se forme sous forme d’or pur (Au0) solide.
- L’acide chlorhydrique (HCl) est formé par l’association des ions chlorure (Cl-) et des ions hydrogène (H+) libérés par l’acide aurichlorohydrique (HAuCl4) et le sulfure de fer(II) (FeS).
- Cette réaction chimique est utilisée dans l’extraction de l’or. Elle permet de séparer l’or des autres métaux qui se trouvent avec lui dans la roche.
Alors que l’or comme l’argent sont toxiques pour certaines bactéries, certaines parviennent à s’en protéger en accumulant le précieux métal ou en le solidifiant.
De plus, certains micro-organismes résistants aux métaux, tels que le comme la bactérie Delftia acidovorans, sont connus pour contribuer à la bio-minéralisation de l’or en excrétant des protéines (par exemple, la delftibactine) dans l’environnement extracellulaire pour se lier et réduire l’or.
Delftia acidovorans possède en fait un mécanisme de défense : lorsque celle-ci détecte des ions d’or aqueux (aureux ou auriques) dans son environnement extérieur, la bactérie sécrète tout autour d’elle une protéine, nommée delftibactine.
En sécrétant de la delftibactine capable de faire précipiter les ions d’or en suspension Delftia acidovorans parvient à créer des structures solides complexes de nanoparticules d’or.
Cette protéine transforme les ions aureux et auriques en nanoparticules d’or, par précipitation, de dimensions situées entre 25 et 50 nm.
Ces nanoparticules d’or s’accumulent ensuite naturellement en petits amas d’or de couleur pourpre, observables au microscope.
Ce mode de bio-minéralisation de l’or est un mécanisme de survie qui peut réduire l’or soluble en le faisant précipiter en nanoparticules d’or.
En général, les complexes Au (III), ainsi que les ions Cu (II), peuvent entrer dans l’espace périplasmique des cellules bactériennes.
Le périplasme est un espace délimité par deux barrières perméables sélectives (membranes biologiques), qui sont la membrane interne cytoplasmique et la membrane externe à Gram négatif des bactéries.
Ces métaux solubles se réduisent au contact de la cellule, formant respectivement Au (I) et Cu (I). Ils sont ensuite transportés dans le cytoplasme (partie de la cellule qui entoure le noyau).
Transformation de la morphologie des particules d’or
L’or dérivé d’une source primaire (par exemple, hydrothermale, porphyre riche en or ou gisements de porphyre riche en or/cuivre) se présente souvent sous forme d’alliage avec des quantités variables d’argent.
Le rapport ou ratio or / argent de ces alliages est une signature qui indique le type de source primaire à partir de laquelle l’alliage est dérivé ; c’est donc une information importante.
L’or peut se présenter sous forme d’inclusions or / argent de tailles micrométriques et de formes irrégulières qui sont hébergées dans un minéral sulfuré polymétallique, in-situ.
La dissolution des sulfures polymétallique est catalysée par des bactéries chimiotrophes, telles que les oxydants de fer ou de soufre.
Il a été démontré que la dissolution catalysée par des bactéries des minéraux sulfurés métalliques contenant de l’or peut libérer des inclusions or / argent.
Les bactéries chimiotrophes sont des organismes unicellulaires (essentiellement procaryotes) qui utilisent l’énergie de l’oxydation de composés chimiques comme source initiale d’énergie chimique. Elles se nourrissent de métaux.
Un procaryote est un micro-organisme unicellulaire dont la structure cellulaire ne comporte pas de noyau, et presque jamais d’organites membranés.
Les procaryotes actuels sont les bactéries et les archées.
A la différence des bactéries photographes, lesquelles utilisent l’énergie lumineuse pour leur métabolisme, les bactéries procaryotes utilisent des composés chimiques, par oxydoréduction pour élaborer leurs propres constituants organiques.
Selon la nature du composé utilisé, minéral ou organique, on en distingue deux grands types :
- les bactéries chimiolithotrophes utilisent des composés minéraux et métallifères. Une bactérie chimiolithotrophe est une bactérie capable d’obtenir son énergie de l’oxydation de composés chimiques inorganiques. Les champignons, les protozoaires et la grande majorité des bactéries sont incapables de faire la photosynthèse.
- les bactéries chimioorganotrophes utilisent des composés organiques. Elles constituent l’immense majorité des eubactéries. Les eubactéries, ou « bactéries vraies », sont un groupe majeur des procaryotes. Selon la théorie des trois domaines, les eubactéries forment un des trois grands clades qui divisent le monde vivant, les deux autres étant les archées et les eucaryotes.
On parle de chimiotrophie pour les organismes qui trouvent l’énergie nécessaire au développement de leurs cellules sans utiliser celle de la lumière du Soleil.
Il a été mis en évidence que les processus bactériens peuvent agir sur les sources de gisements d’or primaires, produisant et libérant ainsi des particules d’or secondaires ; très souvent avec un indice ou titre de pureté d’alliage plus important que celui de l’or présent dans les sources de gisements primaires.
Bien qu’il existe des particules d’or pur, les particules d’or secondaires des placiers du monde entier ont souvent trois caractéristiques structurelles fondamentales :
- un noyau d’alliage or / argent (le nucléus),
- un bord de surface enrichi en or (alliage avec un titre de pureté important),
- et des structures secondaires en or (fusionnés ou agglomérés).
Bien que ces caractéristiques soient communes à toutes les particules d’or, quelque soit leurs tailles, leurs expressions sont très variables et reflètent le parcours unique de la somme de toutes les transformations mécaniques, physiques et chimiques que ces particules d’or ont subi depuis leurs genèses.
L’analyse et l’interprétation des morphologies des particules d’or, par des observations au microscope ou à l’oeil nu, c’est-à-dire les formes, les couleurs sont des informations précieuses, comme j’ai pu l’expliquer plus haut dans cet article.
Ces caractéristiques physiques et visuelles, attribuées à la somme des remodelages mécaniques et chimiques, peuvent être utilisées comme des indicateurs pour déterminer dans quelle mesure les particules d’or ont été transportées depuis leurs origines primaires respectives.
C’est la raison pour laquelle, les meilleurs prospecteurs d’or et orpailleurs ne négligent pas ces études de formes, de couleurs, et des caractéristiques des particules d’or, et ils arrivent grâce à ces observations à localiser l’origine de certains filons ou gisements aurifères durant leurs prospections aurifères.
Alors que la prise en compte du ratio or / argent des échantillons et des prélèvements peuvent indiquer l’origine des particules d’or, l’indice de l’enrichissement en or (la pureté ou le titre) des particules d’or révèlent l’étendue de l’altération biogéochimique que les particules subissent dans des conditions proches de la surface.
L’enrichissement en or est souvent caractérisée par des couches successives qui se superposent et s’accumulent à la surface du bord extérieur des particules d’or ; celles-ci grandissent et vont croître au fil des années.
Cependant ce processus est plus complexe que cela n’y parait car il y a des phases de dissolution ou solubilisation d’or à la surface et des phases de dépôts ou d’accumulation d’or à la surface, qui sont variables en fonction des conditions physico-chimiques de l’environnement et de l’impact du travail des micro-organismes eux-même.
Ces couches de dépôts (comme les anneaux de croissance d’une coupe transversale d’un arbre) peuvent varier en épaisseur et sont souvent composées d’or très pur (avec un titre > 99%) ; la composition de l’alliage des couches varie aussi au fil du temps et des apports successifs en fonction de la disponibilité des métaux (Au, Ag, Cu, Fe, Mn) dans l’environnement immédiat extérieur à proximité.
Il faut prendre en considération et imaginer qu’avec l’augmentation des nanoparticules d’or produites par les bactéries et les micro-organismes, de part leurs vies métaboliques et leurs interactions bio-géochimiques, cela implique une augmentation infinie de la variabilité structurelle des possibilités de formes des grains et des paillettes d’or observées.
En outre, la solubilisation de l’or à partir de particules d’or présentes dans l’environnement extérieur par les bactéries va favoriser en amplifier la réduction ultérieure des complexes chimiques d’or solubilisés sous la forme de déchets rejetés par les bactéries impliquées, en nanoparticules plus abondantes et en leur permettant de grossir avec le temps.
La boucle est bouclée, présentant un cycle vertueux et perpétuel, tant que les bactéries sont actives et fonctionnelles.
L’or secondaire bactérien formera des nanoparticules plus abondantes en milieu aqueux aurifère et cela permettra aux nanoparticules de grossir progressivement, tant qu’il y aura un apport de complexes chimiques aurifères en solutions aqueuses dans l’environnement extérieur.
Donc sans la vie microbienne, sans la présence d’arbres, de végétaux, de racines, ces processus de recyclages, de concentration et de raffinages de l’or n’existeraient pas dans la Nature, car oui, le fait de trouver des grains, paillettes et pépites d’or, ce « miracle » est directement liés et dépendants de cette Vie sous-jacente. Faits et concepts extraordinaires et vertigineux, qu’il ne faut jamais oublier dans le cadre de vos prospections aurifères.
Additionnellement, les structures et les formes des particules d’or quelque soient leurs tailles, peuvent être physiquement modifiées à cause de remodelages mécaniques.
L’or étant malléable et pliable, aplatissable, il ne faut pas négliger les influences de la puissance mécanique des crues et de la force de l’eau, des altérations morphologiques liées au transport, les impacts mécaniques des éboulements à cause de l’érosion ou de la tectonique ; car les forces mises en oeuvres sont titanesques et perpétuelles.
Finalement, il y a 3 facteurs essentiels à retenir qui contribuent à la variation morphologique des particules d’or au fil du temps :
- les processus d’altérations bio-géochimique, conséquences du rôle des micro-organismes et des bactéries, grâce à leurs besoins métaboliques,
- les processus d’altérations chimiques, conséquences des variation de température, de pH (acide / alcalin), de l’électro-conductivité, de la présence d’oxydes, de sulfures et de métaux,
- Les processus d’altérations mécaniques et physiques, à cause des crues, parce que l’eau et la gravité sont des forces vives.
Les particules d’or qui présentent une plus grande transformation morphologique contiennent également des biofilms bactériens dont l’existence peut être confirmée par l’observation avec des microscopes puissants et par des expériences scientifiques en microbiologies élabores, parfois complexes à mettre en oeuvre.
Aussi, les particules d’or qui présentent une plus grande transformation contiennent également une communauté microbienne plus spécialisée et tolérante aux métaux, ce sont des bactéries métallophytes. Leurs existences sont très anciennes sur Terre, très certainement depuis l’Aube de la Vie sur notre chère planète.
Bien que l’or soit considéré comme un métal inerte, il a été démontré que :
- l’interaction entre les micro-organismes et les particules d’or est bien un fait avéré et prouvé,
- l’influence et l’action des bactéries ont une incidence directe sur la structure et la chimie des particules d’or,
- que les bactéries impliquées dans ces phénomènes ont une plus grande résistance à la toxicité de l’or et d’autres métaux que d’autres bactéries.
Ci-dessous : Un diagramme schématique du cycle biogéochimique de l’or se produisant à la surface d’un placer aurifère. Un agrandissement réalisé avec l’aide d’une micrographie SEM, en fausses couleurs d’une section transversale fraisée par faisceau d’ions focalisés (FIB). Il s’agit ici de l’interface où se produisent les processus de dissolution et de re-précipitation de de l’or par l’action de bactéries.

Transport de l’or secondaire et cinétique du cycle bio-géochimique de l’or
Les microbes et les biofilms contribuent à la dissolution et à la précipitation de l’or, ce sont des petites usines infatigables qui si les conditions le permettent oeuvrent perpétuellement.
En plus des bactéries, divers minéraux argileux, des complexes chimiques contenant du soufre (S) ou du fer (Fe), et d’autres complexes chimiques formés à partir de la réduction des complexes d’or solubles, il a été démontré que de nombreux minéraux et substances chimiques ou organiques agissent comme agents réducteurs pour l’or, favorisant sa précipitation et la formation de nanoparticules d’or.
Des nombreux minéraux naturels se sont avérés agir comme des puissants agents réducteurs et des catalyseurs à la formation (à partir de complexes d’or solubilisé dans l’eau) de nanoparticules d’or dans l’environnement, qui une fois libérés et formés sont mobilisables parfois sur de très grandes distances grâce à l’action de l’eau et de la gravité.
Par exemple, il a été démontré que les argiles et les minéraux contenant du fer (Fe) adsorbent facilement les nanoparticules d’or, et cela aura tendance à accumuler et à concentrer des particules d’or.
En outre, les biofilms bactériens agissent comme de la colle ou de la glue, en piégeant les particules d’or progressivement au fil du temps, ils auront tendance à accumuler et à concentrer des particules d »or.
Aussi, la formation de particules d’or plus grosses à partir de nanoparticules d’or produites par les bactéries est possible grâce à des processus de sédimentation. Ce qu’il se passe c’est que les nanoparticules d’or accumulées s’agrègent et fusionnent créant ainsi des particules d’or complètement composées d’or secondaire, visibles sous la forme de grains, paillettes, ou pépites d’or.
Comme je l’ai expliqué plus haut, cet or formé grossira et croîtra et il aura un indice de pureté de de titre très pur, parfois > 98%.
Cet or secondaire formé au fil du temps, sera ensuite mobilisé et transporté, parfois sur de très longues distances, par l’eau, la gravité, et d’autres facteurs. Il pourra être aussi à nouveau solubilisé chimiquement, et transporté en solutions aqueuses dans le sol, les rivières…
Il faut souligner que certains environnement naturels, comme par exemple les zones tropicales, sub-tropicales, les zones forestières, les zones humides et montagneuses, sont plus propices au développement de la vie microbienne participant au Cycle de l’Or, et ces zones sont plus propices à la formation de placiers d’or secondaires que d’autres.
Il faut pour cela de l’eau, de la Vie microbienne in-situ dans la terre, de la végétation, des arbres, de la mousse, des lichens, des champignons, de la faune et de la flore.
Donc oui, le Vie, le Biotope et la diversité contribue à la formation et à la libération dans l’environnement de particules d’or secondaires, et à la formation de placiers aurifères, au delà des aspects mécaniques et physiques (eau, failles, marmites, crevasses,…).
Cette prise de conscience doit aussi permettre, sur le long terme, de contribuer à la préservation des écosystèmes sur l’ensemble de notre planète, et de reconsidérer notre place et notre rôle pour jouir durablement des bienfaits de la Nature avec toute humilité et sagesse qui s’impose.
La vie organique en interaction avec l’or
Les micro-organismes capables de solubiliser et de précipiter activement l’or semblent jouer un rôle plus important dans le cycle biogéochimique de l’or qu’on ne le croyait auparavant.
Des recherches récentes suggèrent que les bactéries et les archées sont impliquées dans chaque étape du cycle biogéochimique de l’or, de la formation de la minéralisation primaire dans les systèmes hydrothermaux et souterrains profonds à sa solubilisation, dispersion et reconcentration en or secondaire à la surface.
Dans ce chapitre, je vais vous présenter sommairement quelques exemples concrêts de cas d’interactions entre certaines bactéries et archées avec l’or ou des complexes chimiques aurifères.
Des précipitations d’or catalysées enzymatiquement ont été observées dans des bactéries et archées thermophiles et hyperthermophiles (par exemple, Thermotoga maritime, Pyrobaculum islandicum), et leurs activités ont conduit à la formation de minerais agglomérés aurifères et argentifères dans les systèmes de sources chaudes de Nouvelle-Zélande.
Les bactéries sulfato-réductrices (SRB), par exemple Desulfovibrio sp., peuvent être impliquées dans la formation de minéraux sulfurés aurifères dans des environnements souterrains profonds ; à des échelles de temps géologiques, cela peut contribuer à la formation de gisements aurifères économiques considérables.
Les bactéries oxydant le fer et le soufre (par exemple, Acidothiobacillus ferrooxidans, Acidithiobacillus thiooxidans) sont connues pour décomposer les minéraux sulfurés hébergeant de l’or dans les zones de minéralisation primaire et libérer l’or associé dans le processus dans la nature. Un puissant allié du weathering.
Ces bactéries et d’autres (par exemple, les actinobactéries) produisent du thiosulfate, qui est connu pour oxyder l’or et former des complexes aurifères stables et transportables sur de longues distances.
D’autres processus microbiens, par exemple l’excrétion d’acides aminés et de cyanure, peuvent contrôler la solubilisation de l’or dans les sols aurifères supérieurs et rhizosphériques. La rhizosphère est la région du sol directement formée et influencée par les racines et les micro-organismes associés qui font partie du microbiote des plantes.
Un certain nombre de bactéries et archées sont capables de catalyser activement la précipitation de complexes aureux ou auriques toxiques.
La précipitation réductrice de ces complexes peut améliorer les taux de survie des populations bactériennes capables :
- de détoxifier l’environnement cellulaire immédiat en détectant, excrétant et réduisant les complexes d’or (par exemple, Salmonella enterica, Cupriavidus (Ralstonia) metallidurans, Plectonema boryanum),
- de gagner de l’énergie métabolique en utilisant des ligands complexant l’or (par exemple, le thiosulfate d’Acidithiobacillus ferrooxidans),
- d’utiliser l’or comme centre métallique dans les enzymes (exemple : Micrococcus luteus).
La bactérie Cupriavidus metallidurans contenant des biofilms ont été détectés sur des grains d’or provenant de deux sites australiens, ce qui indique que la bioaccumulation de l’or peut conduire à une bio-minéralisation de l’or en formant de l’or bactérioforme secondaire.
La formation de cristaux d’or octaédriques secondaires à partir d’une solution de chlorure aurique a été favorisée par une cyanobactérie (P. boryanum) via un intermédiaire sulfure d’or amorphe.
L’or bactérioforme et les cristaux d’or secondaire sont courants dans les conglomérats de galets de quartz, où ils sont souvent associés à des matières organiques bitumineuses éventuellement dérivées de cyanobactéries.
Cela peut suggérer que les cyanobactéries ont joué un rôle dans la formation du Witwatersrand en Afrique, le plus grand gisement d’or du monde.
Les micro-organismes jouent un rôle important dans le cycle géochimique des métaux.
Ces cycles métalliques sont entraînés par des micro-organismes, car les métaux sont essentiels à la nutrition microbienne (par exemple, Mg, Na, Fe, Co, Cu, Mo, Ni, W, V, Zn).
Un certain nombre d’ions métalliques sont oxydés ou réduits dans les réactions métaboliques pour gagner de l’énergie, et contribuent au développement et à la croissance de la vie de certains micro-organismes.
La solubilisation, la précipitation, le fractionnement et la spéciation des métaux et des ions métalliques sont également indirectement influencés par l’activité microbienne, par exemple par leur influence sur les conditions réduction/oxydation environnementales et le pH, la formation de ligands complexants et la bio-accumulation de l’or.
Dans d’autres études scientifiques, les actions microbiennes sur les métaux et les métalloïdes de Fe, Mn, As, S, V et U (par exemple : oxydation, réduction, méthylation, complexation et biominéralisation), ont été liés au cycle biogéochimique des métaux dans les sédiments, les sols et autres substrats altérés des régions polaires, tempérées, arides et tropicales.
Contrairement aux métaux mentionnés ci-dessus, l’or est extrêmement rare, inerte, non essentiel, instable en tant qu’ion libre dans une solution aqueuse dans des conditions de surface, et en tant que complexe, il peut être hautement toxique pour les organismes.
Des études en laboratoire ont montré que certaines archées, bactéries, champignons et levures sont capables de solubiliser et de précipiter l’or dans des conditions in vitro, mais ces expériences ne donnent que des informations limitées sur la solubilisation et la précipitation de l’or catalysées par des communautés microbiennes complexes dans des environnements naturels.
Dans une approche basée sur le terrain, la morphologie des grains d’or secondaires qui présentent des structures bactérioformes a été utilisée comme preuve de la précipitation microbienne d’or et de la bio-minéralisation dans l’environnement.
Ils peuvent jouer le rôle de possibles bio-indicateurs, dans la recherche de gisements aurifères, pour les prospecteurs.
Les bactéries, des usines à nanoparticules d’or
Le terme bactérie est un nom qui désigne certains organismes vivants microscopiques et procaryotes présents dans tous les milieux.
Le plus souvent unicellulaires, elles sont parfois pluricellulaires (généralement filamenteuses), la plupart des espèces bactériennes ne vivant pas individuellement en suspension, mais en communautés complexes adhérant à des surfaces au sein d’un gel muqueux (biofilm).
Les cellules procaryotes sont des cellules sans noyau qui regroupent principalement le monde des bactéries. Composition d’une bactérie : Cytoplasme. Chromosome bactérien.
Le terme de microbes, est très souvent employé de manière populaire pour désigner les bactéries.

Le sol est composé de matière minérale provenant de l’érosion des roches et de matière organique (l’humus) provenant de la décomposition partielle des végétaux.
L’humus est la couche supérieure du sol créée, entretenue et modifiée par la décomposition de la matière organique, principalement par l’action combinée des animaux, des bactéries et des champignons du sol.
L’humus est une matière souple et aérée, qui absorbe et retient bien l’eau, de pH variable selon que la matière organique est liée ou non à des minéraux, d’aspect foncé (brunâtre à noir), à l’odeur caractéristique, variable selon qu’il s’agit d’une des nombreuses formes d’humus forestier, de prairie, ou de sol cultivé.
L’humus se distingue du compost par son origine naturelle, mais partage avec lui beaucoup de propriétés, notamment sa capacité à retenir l’eau et les nutriments. Dans le compartiment de la biosphère qu’est le sol, l’humus est la partie biologiquement la plus active.
C’est dans les zones tempérées qu’il est le plus abondant, mais on a récemment redécouvert et étudié une sorte d’humus ancien et d’origine humaine en Amazonie : la terra preta, ou terre noire.
L’humus est absent des déserts et, plus généralement, de tout milieu dépourvu de végétation (la haute montagne, par exemple).
L’humification est un processus biochimique de néosynthèse de substance organique par augmentation de la taille de certaines molécules.
La capacité d’échange naturelle d’un humus ainsi que sa décomposition lente délivrent aux racines des plantes de l’azote, du phosphore et tous les éléments nutritifs indispensables à la croissance des végétaux.
Si l’humus est enfoui par labour ou asphyxié (inondation durable, compression, bâchage étanche), il se dégrade et libère des composés toxiques ainsi que du méthane.
D’où l’importance de le préserver et d’en prendre soin.


« L’humus, fondement de la vie. Il nous faut insister maintenant sur l’importance vitale de cette matière que nous venons de voir apparaître, c’est-à-dire l’humus. Le définir en une simple formule chimique est impossible. Il n’y a pas un humus, mais des humus, qui varient avec les sols, les climats et les végétations, tandis que l’on rencontre dans les sols des matières organiques à toutes les étapes de leur transformation, les unes encore jeunes, les autres, presque totalement ou totalement transformées. » — André Birre, Une autre révolution : pour se réconcilier avec la terre, 1976

Dans l’humus, la flore microbienne y est très variée.
Elle comprend des bactéries, des champignons, des protozoaires, des algues, des virus, mais les bactéries sont les représentants les plus importants quantitativement, elles représentent presque + 90% de la masse totale.
On peut y retrouver tous les types de bactéries, des autotrophes, des hétérotrophes, des aérobies, des anaérobies, des mésophiles, des psychrophiles, des thermophiles.
Tout comme les champignons, certaines bactéries sont capables de dégrader des substances insolubles d’origine végétale comme la cellulose, la lignine, de réduire les sulfates, d’oxyder le soufre, de fixer l’azote atmosphérique et de produire des nitrates.
Les bactéries jouent un rôle dans le cycle des nutriments des sols, et sont notamment capables de fixer l’azote.
Elles ont donc un rôle dans la fertilité des sols pour l’agriculture.
Les bactéries abondent au niveau des racines des végétaux avec lesquels elles vivent en mutualisme.
À la différence des milieux aquatiques, l’eau n’est pas toujours disponible dans les sols.
Les bactéries ont mis en place des stratégies pour s’adapter aux périodes sèches.
Dans le sous-sol, dans l’eau ou dans les cavités humides, des bactéries colonisent inévitablement les galeries minières, puits de mines et leurs abords faillés ou évidés, y compris dans les centres de stockage souterrains ; elles sont parfois trouvée à grande profondeur dans le sous-sol, y compris dans les remontées de forages d’eau ou de pétrole.
Elles peuvent là aussi modifier leur environnement, être source de CO2 ou de méthane, d’acidification, de corrosion, de méthylation, de putréfaction et/ou interagir avec les nappes, certains métaux ou des matériaux de confinement.
Les bactéries peuvent aussi être rencontrées dans des environnements plus extrêmes.
Elles sont qualifiées d’extrémophiles. Des bactéries halophiles sont rencontrées dans des lacs salés, des bactéries psychrophiles sont isolées d’environnements froids comme des océans Arctique et Antarctique, des banquises. Des bactéries thermophiles sont isolées des sources chaudes ou des cheminées hydrothermales.
Les biofilms des bactéries se développant et prospérant sur les grains d’or jouent un rôle majeur dans le cycle bio-géochimique de l’or.
Les bactéries favorisent la dispersion de l’or dans la nature, via la formation de nanoparticules d’or, et cela contribue à la formation d’or dans les gisements aurifères secondaires.
Les grains et les paillettes d’or sont couverts par une couche polymorphe organique-inorganique pouvant mesurer jusqu’à 40 µm d’épaisseur, très souvent invisible à l’oeil nu, mais observable au microscope.
Les études et recherches scientifiques démontrent que les activités bactériennes permettent:
- la dissolution, la précipitation et l’agrégation conduisant à la formation de nanoparticules d’or et contribuent à la croissance des grains ou des paillettes d’or, essentiellement dans des conditions d’environnements supergènes (très riche en oxygène).
- la mobilisation microbienne de l’or en nanoparticules qui joue un rôle clé dans la mobilité de l’or dans les environnements de surface, car la libération de nanoparticules d’or pendant la désintégration du biofilm bactérien améliore considérablement la mobilité environnementale comparé aux complexes aqueux chimiques aureux et auriques.
Malgré sa faible solubilité dans les eaux souterraines et de surface, l’or est très mobile dans les environnements de surface, ce qui entraîne son enrichissement dans les sols et les placers, formant des gisements d’or secondaires, pouvant parfois avoir un intérêt économique.
Les minéraux colloïdes, les nanoparticules, et les cellules bactériennes peuvent augmenter la mobilité environnementale des métaux peu solubles tels que cuivre ou l’or dans les environnements de surface.
La solubilisation de l’or et la formation d’or sous la forme de nanoparticules est directement lié dans à l’action des biofilms bactériens sur des surfaces de grains d’or :
- Les biofilms agissent comme des usines de nanoparticules efficaces, recyclant continuellement l’or grossier et libérant l’or en nanoparticules dans l’environnement.
- Les biofilms bactériens augmentent la mobilité de l’or dans la nature, qui peut être déplacé sur de longues distances.
- Les biofilms bactériens ont été observés sur des grains et des paillettes d’or prospérant dans des sols aurifères, où leur présence conduit à un doublement de la solubilisation de l’or, mais les mécanismes de mobilisation et de dispersion restent encore mystérieux.
Les bactéries cyano-, sulfi-désoxydantes, sulfato-réductrices, et métallophiles contribuent à la bio-minéralisation des nanoparticules d’or, en provenance de complexes aqueux en solution dans l’eau, composés ions aureux Au(I) et auriques Au(III).
En leur présence, les nanoparticules d’or vont s’agréger, se transformant en cristaux d’or, pendant plusieurs semaines, mois ou années, et vont évoluer en étant enroulés ou en fils d’or, avec des structures irrégulières et arrondies qui sont morphologiquement similaires aux formes que pourraient avoir les bactéries.

Les grains, paillettes ou pépites d’or de dimensions situées entre 0,1 et 4 mm de diamètre sont la source la plus abondante d’or alluvial et éluvial et peuvent constituer des gisements d’or secondaire d’intérêts économiques importants.
Les grains d’or et les pépites d’or sont hypogènes à l’origine ; leur apparition dans des environnements de surface révèle l’altération des roches abritant minéralisation auroifère primaire et leur distribution dépend de l’accumulation mécanique dans le environnements, grâce notamment aux processus induits par le weathering.
En géologie, un processus hypogène qualifie une formation résultant de phénomènes géologiques d’origine profonde, par opposition au processus supergène qui correspond aux phénomènes géologiques superficiels.
Ils sont principalement composés d’alliages Au / Ag, mais ils ont une très grande pureté (jusqu’à 99,9% en poids Au) par rapport à l’Au primaire du gisement initial (source), parce que l’argent est se délocalise facilement, il est encore plus soluble et mobile que l’or dans la nature.
Les biofilms bactériens on la capacité de :
- catalyser la formation et croissance d’or secondaire,
- de mobiliser et disperser, libérer l’or dans l’environnement.
La biominéralisation de l’or mobile à partir d’une solution / suspension améliore la croissance des grains dans des environnements de surface, ce qui peut expliquer pourquoi les grains d’or secondaire sont souvent plus grossiers que l’or encastré dans la minéralisation primaire associée.
L’altération des sulfures des gisements primaires peut entraîner mobilisation et dispersion de l’or présent sous forme de solution solide, pour former de l’or secondaire pur (grains, paillettes, pépites d’or).
Les biofilms jouent un rôle dans la libération de la dispersion de or en agissant comme des usines de nanoparticules efficaces.
Puisque les biofilms sont sujets à des cycles perpétuels de formation et destruction :
- à cause d’alternances de périodes de dessiccation (séchage) et de réhumidification (épisodes pluvieux ou apport d’eau),
- à cause de l’action du pâturage par le faune présente dans le sol ou en surface,
- à cause des actions du monde végétal (décomposition des feuilles, développement racinaire),
- à cause des phénomènes météorologies et d’érosions, l’or en nanoparticules sera périodiquement libérés et dispersés dans l’environnement.
La libération continue d’or en nanoparticules explique la forte mobilité de l’or dans de nombreux environnements proches de la surface, ce qui conduit à la formation de gisements secondaires d’or.

Dans certaines études récentes sur la bio-géo-microbiologie de l’or, il a été suggéré que les processus microbiens peuvent avoir a eu une influence beaucoup plus grande sur la formation de gisements d’or secondaires sur Terre, tels qu’on le pensait auparavant.
Les interactions entre tectonique et la biosphère ont peut-être entraîné des changements dans la géochimie mondiale, qui ont généré des conditions plus appropriées pour l’absorption de l’or inclus dans les gisements de sulfures métalliques (par exemple : la pyrite (suflure de fer), la chalcopyrite (sulfure de fer et de cuivre), la galène (surfure de plomb argentifère), la blende (sulfure de zinc),…).
En prenant en considération que les bactéries anaérobies et hétérotrophes aptes interagir avec l’or sont actives depuis 3,5 milliards d’années, elles sont parvenue à libérer d’importantes quantités d’or secondaires, comme étant un sous-produit de leurs vies métaboliques et de leurs existences, et libérant aussi d’autres produits comme le sulfate, le thiosulfate ou du sulfure d’hydrogène (H S).
Certaines bactéries, telles que Desulfovibrio spp. ont la capacité de réduire les complexes aurifères thiosulfate d’or former et libérer des nanoparticules d’or dans la nature ; leurs actions déstabilisent l’or en solution, qui aura tendance à précipiter dans les bactéries in-situ, ou à être incorporé dans les minéraux de soufre nouvellement formés, comme par exemple dans la pyrite sédimentaire.

Mécanisme de synthèse microbienne des nanoparticules d’or :
- Les nanoparticules d’or AuNP sont formés par diverses bactéries métallophytes, en conditions anaérobie, par l’apport d’hydrogène comme source d’énergie principale.
- Le mécanisme sous-jacent commun impliqué dans la synthèse est la réduction des ions Au+3 pour former de l’or en nanoparticules AuNP, grâce à des enzymes, à l’intérieur de la bactérie.
- Des enzymes comme les ligninases, laccases, les reductases, certaines protéines ou acides aminés, la tyrosine, contribuent à la réduction d’or aqueux aurique ou aureux avec la formation de nanoparticules d’or comme sous-produits.
- Les enzymes sécrétées par les bactéries jouent un rôle important dans la réduction des ions métalliques, conduisant à la nucléation et à la croissance des nanoparticules NP, qui sont ensuite expulsées dans l’environnement extérieur, hors du cytoplasme et de la bactérie.
- Dans ce cas, les nanoparticules d’or sont des déchets de la vie métabolique bactérienne.
- L’environnement extérieur joue aussi un rôle essentiel et conditionne ces processus et réactions biologiques : variation de température, pH, concentration d’or en solutions aqueuses, milieu statique ou turbulent.
Ces mécanismes et processus impliqués dans la synthèse de l’or en nanoparticules AuNP sont représentés sur le schéma ci-dessus.

Liste des bactéries produisant des nanoparticules d’or (Au)
Ci-dessous, je vous présente une liste non exhaustive de bactéries qui produisent des nanoparticules d’argent dans la Nature.
La colonne de gauche présente le nom des bactéries, la colone size (taille) indique les dimensions moyennes des nanoparticules d’or observées, la colonne shape indique la forme des nanoparticules d’or observées, la colonne localization précise l’endroit de la présence des nanoparticules d’or par rapport à la cellule bactérienne.

Liste des bactéries produisant des nanoparticules d’argent (Ag)
Ci-dessous, je vous présente une liste non exhaustive de bactéries qui produisent des nanoparticules d’argent dans la Nature.
La colonne de gauche présente le nom des bactéries, la colone size (taille) indique les dimensions moyennes des nanoparticules d’argent observées, la colonne shape indique la forme des nanoparticules d’argent observées, la colonne localization précise l’endroit de la présence des nanoparticules d’argent par rapport à la cellule bactérienne.



Comme vous pouvez le constater, il existe une incroyable diversité de types de bactéries qui interagissent avec l’or et l’argent, ce sont chacune des usines à nanoparticules d’or, qui réduisent l’or en solution aqueuse dissout et en solution dans l’environnement, pour former des particules d’or secondaires.
Ces bactéries peuvent être utilisées comme des bio-indicateurs, dans le cadre de la prospection aurifère et de la recherche de gisements d’or secondaires.
Ces bactéries sont des usines productrices d’or secondaires, dont l’or est un déchet, un sous-produit de leurs vies métaboliques microbienne, elles jouent le rôle de raffineuses et de purificatrices de l’or en provenance des gisements primaires ou en provenance de l’or dissout en solutions aqueuses présents dans l’environnement terrestre et dans le sol.
Les archées
Les archées, ou Archaea (du grec ancien ἀρχαῖος, « originel, primitif »), anciennement appelés archéobactéries, sont des microorganismes unicellulaires procaryotes, c’est-à-dire des êtres vivants constitués d’une cellule unique qui ne comprend ni noyau ni organites, à l’instar des bactéries.

D’apparence souvent semblable à ces dernières, les archées ont longtemps été considérées comme des bactéries extrêmophiles particulières, jusqu’à ce que les recherches phylogénétiques sur les procaryotes, commencées en 1965, aboutissent, avec les travaux de Carl Woese et George E. Fox, à la publication en 1977 d’un arbre phylogénétique fondé sur les séquences des gènes d’ARN ribosomique des organismes étudiés, arbre dans lequel les procaryotes étaient scindés en deux domaines distincts, celui des bactéries et celui des archées.
On sait aujourd’hui que l’arbre des eucaryotes prend naissance parmi des archées d’Asgård.
Les archées d’Asgård (Asgardarchaeota), ou simplement Asgards, forment un super-embranchement d’archées découvert en 2015 dans des sédiments profonds à proximité du château de Loki, une source hydrothermale au large de la Norvège.
Ils ont été nommés d’après le domaine des dieux dans la mythologie nordique. Les Asgards partagent des traits que l’on croyait réservés aux eucaryotes.
De ce fait, on considère généralement que le clade qui les inclut, comprend aussi les Eukaryota, à ceci près que ces derniers sont issus de l’endosymbiose d’au moins une α-protéobactérie (devenue leur mitochondrie) et ne sont plus des « procaryotes » et donc plus des archées.
Ce clade élargi est dénommé Eukaryomorpha.
Cette approche signe la fin du modèle à trois domaines, les Archées devenant un groupe paraphylétique à la base des Eukaryota.

Ainsi les archées forment un clade avec les Eukaryota mais constituent un groupe paraphylétique situé à la base de ces derniers.
Du point de vue de leur génétique, leur biochimie et leur biologie moléculaire, les archées sont des organismes aussi différents des bactéries que des eucaryotes.
Les enzymes réalisant la réplication de l’ADN, la transcription de l’ADN en ARN ainsi que la traduction de l’ARN messager en protéines chez les archées sont apparentées à celles des eucaryotes et non à celles des bactéries, de même que la présence d’histones dans le matériel génétique des archées rapproche ces dernières des eucaryotes et les distingue des bactéries.
Les eucaryotes (Eukaryota) sont un domaine regroupant tous les organismes, unicellulaires ou multicellulaires, qui se caractérisent par la présence d’un noyau et généralement d’organites spécialisés dans la respiration, en particulier mitochondries chez les aérobies mais aussi hydrogénosomes chez certains anaérobies.
On le distingue classiquement des deux autres domaines que sont les bactéries et les archées (mais le clade des eucaryotes s’embranche en fait parmi ces Archées).
Les eucaryotes rassemblent trois grands règnes du monde du vivant : les animaux, les champignons, les plantes, et d’autres (par exemple les algues brunes).
Les eucaryotes unicellulaires sont parfois regroupés sous le terme de « protistes » et les non-eucaryotes sous la dénomination de « procaryotes » (ces deux derniers groupes étant paraphylétiques).
Les eucaryotes peuvent se reproduire de manière sexuée (par méiose et fusion de gamètes) ou non (par mitose).
Dans la mitose, une cellule se divise pour produire deux cellules génétiquement identiques.
Dans la méiose, la réplication de l’ADN est suivie de deux cycles de division cellulaire pour produire quatre cellules filles haploïdes.
Celles-ci agissent comme des cellules sexuelles (gamètes).
Chaque gamète ne possède qu’un seul ensemble de chromosomes, chacun étant un mélange unique de la paire correspondante de chromosomes parentaux résultant d’une recombinaison génétique au cours de la méiose.

D’autre part, certaines archées possèdent des voies métaboliques qui n’existent ni chez les bactéries ni chez les eucaryotes, comme la méthanogenèse chez les archées méthanogènes, tandis que les archées dans leur ensemble sont dépourvues d’acide gras synthase, contrairement à la fois aux bactéries et aux eucaryotes : elles font un usage très limité des acides gras, et leur membrane plasmique est constituée essentiellement d’étherlipides, à la différence des bactéries et des eucaryotes.

Les archées ont longtemps été vues comme des organismes essentiellement extrêmophiles présents notamment dans les sources hydrothermales océaniques, les sources chaudes volcaniques ou encore les lacs salés, mais on en a découvert depuis dans toute une variété de biotopes qui ne sont pas nécessairement extrêmes, tels que le sol, l’eau de mer, des marécages, la flore intestinale et orale et même le nombril humain.
Les archées seraient particulièrement nombreuses dans les océans, et celles faisant partie du plancton constitueraient l’un des groupes d’organismes les plus abondants de la Terre.
Les archées interviennent par ailleurs de façon non négligeable dans le cycle du carbone et le cycle de l’azote.
On ne connaît pas vraiment d’exemple d’archée pathogène ou parasite commensales.
Les archées méthanogènes de l’intestin humain et des ruminants participent ainsi favorablement à la digestion.
Les champignons
Certains champignons interagissent avec les complexes aurifères des substances organiques des sols, et certains accumulent, concentrent ou attirent l’or.
C’est le cas par exemple du champignon Fusarium Oxysporum, un champignon parasite terrestre qui provoque chez le bananier la maladie de Panama, appelée aussi fusariose du bananier ou jaunisse fusarienne.
Ce champignon fongique qui peut être invasif a aussi un impact sur le plants de tabac en zones tropicales, et est responsable de graves problèmes agricoles.
Fusarium oxysporum est une espèce de champignons ascomycètes de la famille des Nectriaceae.
Comme c’est le cas de tous les Fusarium, il s’agit de la forme de reproduction asexuée d’un ascomycète, mais son téléomorphe est inconnu.
Fusarium oxysporum est un complexe d’espèces telluriques, ubiquistes, parasites de plantes, comprenant de nombreuses formes spéciales, qui infectent collectivement plus de 100 hôtes différents, provoquant des pertes économiques importantes chez de nombreuses plantes cultivées comme le bananier, le cotonnier, le melon, la tomate, etc…
Une variété australienne est capable de dissoudre l’or de la roche et de le concentrer dans son mycélium, ce qui ouvre des perspectives en matière de prospection, en tant que bio-indicateur.
- Lire l’article à ce sujet ici : This Fungus Mines For Gold, Then Wears It
- et cet article intitulé : Evidence for fungi and gold redox interaction under Earth surface conditions
- et cet article : Scientists Discover Fungus That Collects Gold From Its Environment

Les plantes
Il a été prouvé, via de nombreuses études scientifiques, que de l’or circule dans la sève des plantes ou des arbres, grâce aux racines, et s’accumule dans les feuilles qui tombent pendant l’hiver.

Années après années, ses infimes particules d’or emprisonnées dans les feuilles mortes, sont libérées par l’action de la décomposition, aux bactérie bactéries.
Ainsi, les arbres et les plantes sont des usines qui transportent de l’or en nanoparticules ou en solutions aqueuses grâce à la sève depuis une grande profondeur, pour le libérer au final en surface.
Au fil des années, cela peut représenter des stocks ou des accumulations relativement importantes d’or secondaire, visibles ou invisibles.
Bien sûr, pour que ces processus fonctionnent, il doit y avoir des sources de gisements d’or primaire dans le sol, à plus ou moins grandes profondeurs.
Le rôle d’autres micro-organismes et des processus physico-chimiques vont ensuite déplacer, transporter, puis concentrer l’or sur place ou très loin à de grandes distances.
Il y a même des études qui ont été réalisées, et qui ont quantifié, notamment aux USA, dans les années 70’s, quelles espèces de plantes étaient les plus propices à l’absorption de l’or (voir les références en fin d’article).

Donc oui, dans les lieux aurifères, il y a de l’or dans le feuilles des arbres et des plantes, mais invisible, de dimensions moléculaires ou atomiques.
Il est bien établi que l’or se trouve dans la végétation ; des processus naturels existent par lequel l’or peut être solubilisé et absorbé par les plantes, les arbres les végétaux.
Il existe une corrélation entre l’or absorbé par les plantes et la stabilité du chlorure, du bromure et complexes de cyanure aurifères.
Le coefficient d’absorption par les végétaux augmente du chlorure au bromure en passant par les complexes de cyanure aurifères, qui correspond à l’ordre d’augmentation de la stabilité des complexes.
En résumé, l’or colloïdal n’est pas absorbé par les plantes, seul l’or à l’état ionique, associé à des complexes aurifères stables est absorbé par les plantes ou les arbres.
Il est également disponible dans les zones aurifères habitées par des organismes cyanogéniques.
Les chlorures d’or
- Dans certaines conditions, l’or sous forme de chlorure d’or aqueux à pH 6,2 est absorbé par les plantes, pour être stocké dans les feuilles.
Les bromures d’or
- L’or dans les solutions aqueuses de bromure d’or est plus facilement absorbé par les plantes.
- Le bromure d’or peuvent être réduits par l’action des racines des plantes à pH 6,2.
Les iodures d’or
- Les solutions aqueuses d’iodure d’or et de thiocyanate d’or ont plutôt tendance à être toxique pour les plantes, et l’absorption d’or est plutôt irrégulière.
Les thiosulfates d’or
- Les solutions aqueuses de thiosulfate d’or se comportent de la même manière que le chlorure d’or.
Les cyanates d’or
- Les solutions aqueuses aurifères de cyanates d’or sont sont les mieux absorbées par les plantes.
- Le complexe d’or le plus fortement absorbé par les végétaux est le complexe de cyanure.
Certaines compagnies minières envisagent de compter les nanoparticules d’or dans les feuilles de certains arbres, de les quantifier, et d’utiliser ces marqueurs, ces bio-indicateurs, pour découvrir des nouveaux gisements d’or dans le sol :
- Natural gold particles in Eucalyptus leaves and their relevance to exploration for buried gold deposits relevance to exploration for buried gold deposits, par Melvyn Lintern, Ravi Anand, Chris Ryan, David Paterson, publié en 2013 par la revue Nature : https://www.nature.com/articles/ncomms3614
L’étude quantitative du nombre de particules (très petites) d’or dans les feuilles des plantes ou des arbres peuvent révéler la présence de gisements aurifères plus profondément enfouis, c’est le cas par exemple des arbres Eucalyptus.
Les micro-organismes qui interagissent avec l’or
Archée: Pyrobaculum islandicum
Pyrobaculum est un genre d’archées de la famille des Thermoproteaceae.
Il s’agit d’un microorganisme hyperthermophile à Gram négatif en forme de bâtonnet, entouré d’une couche S de sous-unités protéiques.
En conditions anaérobies, ces archées réduisent les nitrates NO3– en azote N2 par dénitrification.
La plupart de ces espèces sont chimiolithoautotrophes en réduisant le soufre ou organotrophes par respiration soufrée ou par fermentation.
Les cellules sont en forme de bâtonnets avec des extrémités presque rectangulaires et mesurent environ 1,5 à 8 μm de long pour 0,5 à 0,6 μm de large.
Elles sont généralement mobiles grâce à des flagelles, ayant une ciliature péritriche ou bipolaire polytriche. Elles forment des colonies rondes de couleur grise à vert foncé.
Les espèces sont ou bien aérobies facultatives ou bien strictement anaérobies.
Leur croissance a été observée sur la levure de bière, le peptone, l’extrait de viande, mais pas sur le galactose, le glucose, le maltose, l’amidon, l’éthanol, le méthanol, le formamide, l’acide formique, l’acide malique, l’acide propionique, l’acide lactique et l’acide acétique.
Pyrobaculum aerophilum a été la première de ces espèces dont le génome a été séquencé.
C’est l’une des rares archées capables de respiration aérobie.
Elle ne peut se développer qu’en présence d’oxygène O2 lorsqu’elle est privée de nitrate NO3–, mais est strictement anaérobie en présence de nitrate.
Elle consomme à la fois des composés organiques et inorganiques lorsqu’elle est en respiration aérobie aussi bien qu’anaérobie ; les densités cellulaires maximum en culture ont été observées sur des substrats organiques complexes tels que la levure de bière, le tryptone et le peptone.
Elle est également capable d’utiliser le soufre élémentaire pour sa croissance.
Elle forme des colonies rondes de couleur jaune grisâtre. Elle se développe à des températures allant de 75 à 104 °C, avec un optimum à 100 °C.
Les souches de Pyrobaculum ont été isolées d’eaux bouillantes à pH neutre ou légèrement basique de solfatares ou de sources hydrothermales peu profondes.
Pyrobaculum aerophilum a été isolé à partir d’un point d’eau de mer bouillante à Ischia, en Italie.

Des précipitations d’or catalysées enzymatiquement ont été observées dans des bactéries et archées thermophiles et hyperthermophiles et leur activité a conduit à la formation de sinters contenant de l’or et de l’argent dans les sources chaudes.
Bactérie:Thermotoga maritime
Thermotoga maritima est une bactérie à Gram négatif hyperthermophile de la famille des Thermotogaceae qu’on trouve dans les sources chaudes et les sources hydrothermales sous-marines.
Comme leur nom l’indique, les bactéries de l’embranchement (phylum) des Thermotogae sont entourées d’une membrane externe en forme de gaine unique rappelant une toge romaine.
Elles possèdent un peptidoglycane mince à la structure particulière — il est réticulé également sur les résidus de D-lysine — entre deux membranes plasmiques dont les lipides diffèrent sensiblement des ceux des autres lignées de bactéries.
Thermotoga maritima se développe à des températures particulièrement élevées, de 55 à 90 °C, avec un optimum vers 80 °C ; c’est la seule bactérie connue capable de vivre à de telles températures, les autres organismes hyperthermophiles étant tous du domaine des archées.
Le génome de T. maritima, qui code 1 877 protéines sur 1,8 mégabases, est d’ailleurs commun à 24 % avec celui de certaines archées, ce qui est le pourcentage de recouvrement le plus élevé observé chez une bactérie, ce qui suggère l’acquisition de capacités hyperthermophiles par transfert horizontal de gènes entre des archées et un ancêtre de cette bactérie, dont la divergence d’avec les autres espèces de bactéries est ancienne.
T. maritima contient les homologues de plusieurs gènes de compétence, ce qui suggère qu’elle dispose d’un système propre d’internalisation de matériel génétique exogène susceptible de faciliter les échanges génétiques entre cette bactérie et l’ADN libre.
En tant qu’organisme chimiotrophe et organotrophe à fermentation aérobie, T. maritima catabolise les oses et les polysaccharides pour produire du dioxyde de carbone CO2 et de l’hydrogène H2.
Elle est également capable de métaboliser la cellulose et le xylane en libérant H2 susceptible d’être utilisé comme combustible alternatif aux énergies fossiles.
Cette espèce est également capable de réduire le fer ferrique Fe3+ pour produire de l’énergie métabolique par respiration anaérobie.
Diverses flavoprotéines et protéines fer-soufre ont été identifiées comme possibles transporteurs d’électrons au cours de la respiration cellulaire.
Cependant, lorsque la cellule se développe en présence de soufre comme accepteur final d’électrons, elle ne produit pas d’ATP mais élimine l’hydrogène H2 produit au cours de la fermentation.

Des précipitations d’or catalysées enzymatiquement ont été observées dans des bactéries et archées thermophiles et hyperthermophiles et leur activité a conduit à la formation de sinters contenant de l’or et de l’argent dans les sources chaudes
Bactérie: Chromobacterium violaceum
Chromobacterium violaceum est un coccobacille anaérobie facultatif non sporulé à Gram négatif présent naturellement dans l’eau et le sol des régions tropicales et subtropicales du globe.
Il produit un antibiotique naturel appelé violacéine, qui pourrait avoir des applications contre des cancers, notamment le cancer du côlon.
Cette bactérie se développe facilement sur l’agar-agar en produisant de petites colonies lisses et convexes aux reflets violets sombres en raison de la production de violacéine.
Son génome complet a été publié en 20033. Elle est capable de dégrader les dépôts de goudron.
Elle peut fermenter le glucose, le tréhalose, la N-acétylglucosamine et le gluconate, mais pas le L-arabinose, le D-galactose et le D-maltose.
Elle présente une résistance élevée à de nombreux antibiotiques.
Dans les environnements naturels, certains microbes, tels que C. violaceum, sont connus pour produire du CN− en tant que sous-produit du métabolisme et il a été démontré qu’ils solubilisent l’or élémentaire.

Bactérie: Desulfovibrio desulfuricans
Desulfovibrio desulfuricans est un genre de bacilles à Gram négatif, pouvant prendre des formes variées (droits, incurvés ou de forme sigmoïde).
C’est un genre des bacilles non sporulés, mesurant de 0,5 à 1,5 µm de large sur 2,5 à 10,0 µm de long et mobiles grâce à un unique flagelle polaire ou parfois une ciliature lophotriche.
Les espèces du genre Desulfovibrio sont parfois halophiles, anaérobies, à métabolisme généralement respiratoire (respiration anaérobie), utilisant les sulfates ou d’autres composés soufrés comme accepteurs finaux d’électrons (la réduction conduit à la formation d’hydrogène sulfuré).
Mais elles peuvent être aussi mésophiles, chimio-organotrophes, oxydant de manière incomplète les composés organiques, synthétisant une désulfoviridine (sulfite réductase) et n’hydrolysant pas la gélatine.
On peut retrouver les espèces de Desulfovibrio principalement dans les sédiments ou les boues et l’environnement marin mais aussi dans l’intestin de l’homme et des animaux.
Desulfovibrio desulfuricans est une des bactéries capables de réduire les sulfates en sulfures, puis en hydrogène sulfuré.
Bien qu’étant anaérobie stricte, cette bactérie résiste bien à l’oxygène.
On la retrouve dans les sols, mais aussi dans les vases, même salées, sous les pierres où leur présence est attestée par un dépôt de sulfure de fer noirâtre et une forte odeur d’H2S.
Pour les réactions concernant la respiration anaérobie des espèces de Desulfuvibrio : SO42- + 8 e- + 8 H+ ⇒ S2- + 4 H2O.
L’accepteur final correspond à l’ion sulfate SO24- ; les sulfates sont ainsi réduit en sulfure.
Ce dernier est souvent ensuite réduit en hydrogène sulfureux (H2S).
Ces bactéries sont très importantes pour le recyclage du soufre dans les écosystèmes.
Des quantités significatives de sulfate sont présentes dans presque tous les habitats aquatiques et terrestres, aussi les bactéries réductrices de sulfate sont-elles répandues et actives dans les lieux rendus anoxiques par la digestion microbienne des matières organiques.
Les espèces de Desulfovibrio et d’autres bactéries réductrices de sulfate prospèrent dans des habitats comme les boues et les sédiments des lacs et des cours d’eau pollués, les lagunes et les digesteurs d’eaux dégouts, et les sols gorgés d’eau.
Les bactéries sulfato-réductrices (SRB), comme le Desulfovibrio sp., peuvent être impliquées dans la formation de minéraux sulfurés aurifères dans des environnements souterrains profonds; à des échelles de temps géologiques, cela peut contribuer à la formation de gisements économiques.

Bactérie: Acidothiobacillus ferrooxidans
Acidithiobacillus est un genre d’Acidithiobacillia dans les « Proteobacteria« .
Le genre comprend des organismes acidophiles capables d’oxydation du fer et / ou du soufre.
Comme toutes les « protéobactéries », Acidithiobacillus spp. sont à Gram négatif.
Ce sont également des générateurs importants de drainage minier acide, qui est un problème environnemental majeur dans le monde dans le secteur minier.
A. ferroooxidans gagne de l’énergie métabolique en oxydant le thiosulfate à partir de complexes de thiosulfate d’or, et il a été démontré qu’une enzyme contenant de l’or améliore l’oxydation du méthane.
Les acidithiobacilles sont des autotrophes obligatoires acidophiles (Acidithiobacillus caldus peut également croître de manière mixotrophique) qui utilisent le soufre élémentaire, le tétrathionate et le fer ferreux comme donneurs d’électrons.
Ils assimilent le carbone du dioxyde de carbone.
Le genre comprend des cellules mobiles en forme de bâtonnets qui peuvent être isolées à partir d’environnements à pH bas, y compris des micro-environnements à pH bas sur des grains minéraux autrement neutres.


Les bactéries oxydant le fer et le soufre (par exemple, Acidothiobacillus ferrooxidans, A. thiooxidans) sont connues pour décomposer les minéraux sulfurés hébergeant de l’or dans les zones de minéralisation primaire et libérer l’or associé dans le processus.
Bactérie: Acidithiobacillus thiooxidans
Acidithiobacillus thiooxidans, anciennement connu sous le nom de Thiobacillus thiooxidans jusqu’à sa reclassification dans le nouveau genre Acidithiobacillus de la sous-classe Acidithiobacillia de Proteobacteria, est une bactérie Gram-négative en forme de bâtonnet qui utilise le soufre comme source d’énergie primaire.
Il est mésophile, avec une température optimale de 28 ° C.
Cette bactérie se trouve couramment dans le sol, les tuyaux d’égout et les biofilms des grottes appelés snottites.
A. thiooxidans est utilisé dans la technique minière connue sous le nom de biolixiviation, où les métaux sont extraits de leurs minerais sous l’action de microbes.
A.s thiooxidans se développe à une température optimale de 28-30 ° C.
À des températures plus basses (18 ° C et moins) et à 37 ° C ou plus, l’oxydation et la croissance du soufre sont nettement plus lentes, tandis que des températures comprises entre 55 et 60 ° C sont suffisantes pour tuer l’organisme.


Les bactéries oxydant le fer et le soufre (par exemple, Acidothiobacillus ferrooxidans, A. thiooxidans) sont connues pour décomposer les minéraux sulfurés hébergeant de l’or dans les zones de minéralisation primaire et libérer l’or associé dans le processus. Ces bactéries et d’autres (par exemple, les actinobactéries) produisent du thiosulfate, qui est connu pour oxyder l’or et former des complexes stables et transportables.
Bactérie: Bacillus subtilis
Bacillus subtilis est une bactérie catalase-positive que l’on trouve habituellement dans le sol, mais c’est surtout une espèce omniprésente dans l’environnement.
Sa longueur varie de 2 à 4 µm et sa largeur de 0,5 à 2 µm.
Elle a pour forme cellulaire des bâtonnets droits à bout arrondis.
Elle est mobile grâce à une ciliature péritriche (un système de flagelle qui recouvre tous les côtés de la surface d’une bactérie).
Elle est aérobie stricte, sa température optimale est de 40 °C (espèce mésophile) et son type trophique est chimiohétérotrophe.
Enfin, son temps de génération est d’environ 26 minutes.
Les conditions optimales de croissance de cette souche se situent pour un pH compris entre 5,5 et 8,5, et à une température de 10 °C à 50 °C.
Comme d’autres espèces, B. subtilis peut se constituer une coque protectrice dure (endospore) lui permettant de tolérer des conditions environnementales difficiles ou extrêmes.
Bacillus subtilis a été considérée comme aérobie stricte jusqu’en 1998.
Il s’agit en fait d’une espèce aérobie facultative qui croît en utilisant du nitrate ou du nitrite comme accepteur d’électrons, ou par fermentation.
Elle peut donc survivre à des changements de niveaux d’oxygène dans son environnement.
B. subtilis peut produire ou co-produire des biofilms qui peuvent abriter d’autres espèces, éventuellement pathogènes.
Elle n’est pas considérée comme pathogène pour l’homme, mais elle peut contaminer des aliments et peut exceptionnellement provoquer une intoxication alimentaire.
La bactérie Bacillus subtilis a le pouvoir de réduire l’or soluble aqueux, pour former des nanoparticules d’or élémentaires très petites et minuscules.


Bactérie: Cupriavidus metallidurans, souche CH34
Cupriavidus metallidurans est une bactérie métallophile qui contribue à la diversité bactérienne des biofilms vivant à la surface des particules d’or provenant de nombreux sites, dans le monde entier.
Les processus de bioaccumulation chez C. metallidurans sont liés à la biominéralisation de l’or secondaire.
Les bactéries et cyanobactéries oxydant et réduisant le soufre peuvent être liées à la formation d’or octaédrique secondaire et peuvent avoir contribué à la formation de gisements de placers de galets de quartz.


Le cycle bio-génique de l’or
Ce chapitre est une synthèse et un résumé des travaux réalisés par le prospecteur et le chercheur italien Matteo Oberto, qui a rédigé des publications formidables ; je vous recommande la lecture :
- Ciclo biogenico dell’oro ed esplorazione mineraria (page web ici): https://cercatorioroitalia.altervista.org/images/Oberto/COI5Luglio/5Articolo_COI.pdf
- Il ciclo biogenico dell’oro: https://cercatorioroitalia.altervista.org/editori/matteo-oberto/72-come-si-forma-l-oro-con-i-batteri.html
J’ai aussi rédigé un article sur Matteo Oberto, dont je suis un grand fan de ces travaux ; je vous recommande tous ses livres spécialisés dans la prospection aurifère.
- ABC de l’Orpaillage
- Gold prospecting
- Secondary gold deposits exploration: First edition, 2018 (English versions Book 1) (English Edition)
- Gold
- How to prospect for gold
Il a publié aussi d’autres ouvrages en langue italienne, dont leurs qualités méritent d’être traduits en anglais et en français.
Les ayant tous acheté, je les lis et relis sans modération ! Ils sont une grande source d’inspiration dans le cadre de mes recherches et prospections aurifères, mais aussi pour approfondir mes connaissances à de sujet, et pour expérimenter des nouvelles approches et idées de recherches.
Des bactéries et des micro-organismes, le biofilm bactérien
Dans la nature, il existe des micro-organismes, dont certaines bactéries, qui se développent dans certains types d’environnements, à la surface ou plus profondément dans les sols, vont permettre la formation et la production de grains et de particules d’or, qui vont avoir tendance à grossir progressivement et à augmenter en poids.

(a) couche polymorphe contenant des nanoparticules d’or à la surface d’une dépression du grain d’or;
(b) des biofilms montrant des nanofils dans la dépression du grain d’or;
(c) l’or sphéroïdal secondaire qui se forme dans la dépression du grain d’or.
En résumé :
- Ces bactéries, vivant en colonies ou en communautés microbiennes, constituent des biofilms, et peuvent prospérer directement à la surface des grains et des particules d’or, notamment dans les aspérités, interstices et dépressions infinitésimales.
- Ces bactéries peuvent contribuer à la formation de grains d’or ou à l’augmentation de la taille des grains déjà présents, à la surface ou dans le sol.
- Elles peuvent également jouer un rôle dans la dissolution de l’or, ce qui peut libérer des ions d’or (auriques ou aureux) dans l’eau, en solution aqueuse.
- Celles-ci vont également produire, via leur vies métaboliques, des particules et nanoparticules d’or, des sous-produits de leurs digestions et utilisations, de l’or secondaire avec un indice de pureté et un titre important (> 98%).

Les bactéries jouent un rôle essentiel et insoupçonné, peu connu, dans le Cycle de l’Or et peuvent avoir des implications pour l’exploitation de l’or secondaire et des placiers, voire de jouer le rôle de bio-indicateurs dans le cadre de la recherche de gisements aurifères d’importances économiques.
Les espèces de bactéries identifiées comme participant au cycle de l’or appartiennent à la classe des β–protéobactéries.

L’ensemble des processus est appelé Cycle de l’Or ou Cycle Bio-génique de l’Or, car il est directement en lien avec la vie microbienne de nos sols.
Ces phénomènes bio-chimiques sont présents dans le monde entier, et dans tous les types de climats, et se déroulent perpétuellement et en continu ; cela est du entre autre à l’incroyable éventail et diversité des micro-organismes existants sur la planète, capables d’interagir avec l’or.

Les horizons de l’or
L’or est un métal inoxydable, inerte, et très stable, cependant, grâce à certains complexes chimiques naturels ou biologiques, mais aussi par les variations de pH ou d’électrocondictivité, et sous l’influence d’agents atmosphériques ou la modification de conditions géochimiques, l’or va pouvoir s’oxyder, et se solubiliser en solutions aqueuses auriques ou aureux. Il devient ainsi mobilisable sur de très longue distances.

Ces différents processus et paramètres géo-chimiques présents dans nos sols vont varier et évoluer dans le temps et dans l’espace.
Le sol est formé par la décomposition, la désagrégation, l’oxydation des roches, grâce à l’érosion (actions mécaniques du vent, de l’eau, du gel, des intempéries, les végétaux, les lichens…), l’atmosphère (oxygène), et l’hydrosphère (mer, océan, cours d’eau) ; c’est ce que l’on appelle de weathering.
C’est dans le sol que les processus biologiques des micro-organismes s’y déroulent car de la Vie y prospère, et s’y développent, aussi bien dans des conditions supergènes (en surface, riches en oxygène, aérobie), que hypogènes (en profondeur, pauvres en oxygène, anaérobie).
Ces micro-organismes ou organismes regroupent : bactéries, archées, champignons, racines des plantes, végétaux, la faune, la flore…
Le sol est divisé en plusieurs horizons (ou étages), depuis la surface vers le substrat rocheux ou bedrock (roche mère) en profondeur, sur lequel il repose :
- O: Sol humifère, c’est-à-dire riche en humus, sol riche en matière organique, décomposée en complexes organiques;
- A: horizon dans lequel les fluides de surface s’infiltrent et entraînent avec eux certains éléments, les appauvrissant, horizon dans lequel les éléments sont lessivés par les fluides de surface (processus appelé lixiviation);
- B: horizon dans lequel les fluides enrichis en éléments aurifères par des procédés de lixiviation s’infiltrent et se déposent, enrichissant ainsi le sol en ces éléments. Il peut également contenir de l’or naturellement enrichi, qui peut provenir d’infiltration de fluides d’horizons plus superficiels ou de remontée capillaire de l’horizon C. Cet or peut se présenter sous forme nanoparticulaire, granulaire ou pépiteuse, et être dissous dans des complexes d’or (thiocomplexes ou complexes organiques).
- C: horizon proche du substrat rocheux. Il est formé de fragments de roche qui ont subi une altération chimique et une désintégration mécanique. Ces fragments peuvent contenir des minéraux riches en or, ce qui indique la présence d’une minéralisation dans le substrat. L’horizon C peut également contenir de l’or naturellement enrichi, qui peut provenir d’infiltration de fluides d’horizons plus superficiels ou de dispersion des minéralisations primaires environnantes. Cet or peut se présenter sous forme nanoparticulaire, granulaire ou pépiteuse, et être dissous dans des complexes d’or (thiocomplexes ou complexes organiques).
- R: Le substrat rocheux est la partie de la roche dans laquelle une minéralisation primaire peut être présente. S’il n’est pas fracturé, il joue le rôle d’une barrière imperméable, empêchant les fluides superficiels de pénétrer plus profondément.
En raison de la gravité et de la capillarité, les fluides aqueux enrichis en minéraux, en métaux et en or, qui s’infiltrent ont tendance à descendre dans le sol poreux en traversant les horizons O, A, B C jusqu’à ce qu’il s’arrête au-dessus de l’horizon R.
La hauteur de la nappe phréatique (ou colonne d’eau) varie en fonction de la saison et de la profondeur du sol. Elle dépend de plusieurs facteurs, notamment le climat, les précipitations, l’infiltration de l’eau, l’évaporation et la perméabilité du sol.
En été, les températures sont plus élevées et les précipitations sont moins fréquentes. L’évaporation est donc plus importante, ce qui entraîne une baisse de la nappe phréatique.
En hiver, les températures sont plus basses et les précipitations sont plus fréquentes. L’évaporation est donc moins importante, ce qui entraîne une hausse de la nappe phréatique.
La profondeur du sol joue également un rôle important. La nappe phréatique est généralement plus élevée en surface qu’en profondeur. En effet, les eaux de surface s’infiltrent dans le sol et rejoignent la nappe phréatique.
La perméabilité du sol est également un facteur important. Les sols perméables laissent passer l’eau plus facilement que les sols imperméables. La nappe phréatique est donc généralement plus élevée dans les sols perméables que dans les sols imperméables.
Il est important de noter que le sol n’est pas uniforme en termes de teneur en oxygène.
Certaines zones peuvent être riches en oxygène (hypergène), tandis que d’autres peuvent être très pauvres (hypogène).
Dans les zones pauvres en oxygène, les sédiments peuvent être sujets à l’anoxie.
La présence de biofilms bactériens (colonies bactériennes) dans ces les zones hypogènes doivent s’adapter pour vivre et prospérer et exploiter des processus métaboliques qui n’impliquent pas d’oxygène (bactéries anaérobies), et donc, notamment, mettre à profit les élément métalliques tel que l’or.

Comme il est possible d’observer dans le schéma ci-dessus, l’or n’est pas seulement dispersé dans les zones à proximité de la minéralisation primaire aurifère du substrat rocheux mais peut également être concentrée et mis en mouvement par présence et les activités des colonies bactériennes, par capillarité et les par les remontées via les activités racinaires.
L’or peut aussi être mis en mouvement par les activités de la faune du sol, comme par exemple certains insectes ou certains invertébrés, petits vertébrés ou par la micro-faune qui sont en mesure de déplacer de grandes quantités de substrats dans le sol (exemple : les fourmis, les termites, les lombrics…). Il ne faut pas les négliger non plus dans ces processus de mobilisation de l’or dans le sol, quelque soit sa forme.
Certaines bactéries ont la capacité de mettre en solution l’or primaire du substrat rocheux aurifère, en libérant dans l’environnement des composés organiques, du soufre et d’autres, qui pourraient même déjà présent sans activité bactérienne directe.
L’or massif a une grande sensibilité lorsqu’il est en contact avec des fluides organiques ou des complexes chimiques riches en azote ou en soufre, et il peut être dissout et mis en solution pour incorporer au fil du temps les solutions aqueuses environnantes.
Les arbres à racines profondes enfouies dans le sol de manière étendue et qui ont une végétation haute, comme certaines espèces d’eucalyptus australiens, peuvent absorber grâce à la sève de l’or dissous dans l’eau sous la forme de fluides aqueux aurifères et aussi ils peuvent absorber des nanoparticules d’or qui peuvent s’accumuler dans les feuilles et les branches.
Les racines des plantes absorbent l’humidité des sédiments environnants, y compris l’or dissous dans les complexes chimiques. La sève des arbres permettent le transport vers les feuilles. Au fil du temps, cette absorption peut entraîner une accumulation d’or dans la plante, y compris dans le feuillage et les branches.
Pendant l’automne et l’hiver, ou bien lors de la mort de l’arbre ou de la plante, les feuilles et les branches tombent à la surface du sol, et leurs décompositions grâce aux bactéries et les micro-organismes, ou la micro-faune, vont enrichir progressivement en or au fil des ans l’humus, dans l’horizon O.
Le vent peut aussi soulever et faire voler des feuilles et les transporter sur des longues distances, pour les déposer dans d’autres endroits.
En outre, certains animaux, ou insectes vont transporter des feuilles, brindilles ou branches végétales tombées à la surface ou dans l’humus pour constituer leurs nids ou leurs lieux de vie ou pour s’en nourrir, et contribuent ainsi aux déplacements et au transports de feuilles et de matières végétales. Il en est de même pour les activités humaines.
L’horizon O est très riche en matières organiques et en activités bactériennes qui ont une forte activité et interaction avec l’or.
Grâce aux intempéries et aux précipitations apportant de l’eau qui se minéralise au contact de la surface et du sol (neige, pluie), l’or présent dans l’horizon O est dissout en solution aqueuse aurifère ou précipite localement selon les condition physico-chimiques, et l’or est remis en circulation plus profondément dans les horizons A, B, C et R.
Grâce aux infiltration d’eau successives, les fluides qui contiennent les complexes d’or vont s’infiltrer plus profondément dans le sol, passant par l’horizon A, B, C jusqu’au substrat rocheux ou bedrock l’horizon R.
C’est la raison pour laquelle, finalement, il y a la génération d’un panache aurifère composé de particules d’or, de nanoparticules d’or ou de solutions aqueuses aurifères qui a comme point d’origine les parties adjacentes à l’arbre et qui plonge vers les bas profondément dans le sol dans le système racinaire, en suivant le sens d’écoulement des infiltrations de l’eau.
La genèse des pépites d’or

Sous l’effet des infiltration des eaux minéralisées en provenance de l’horizon 0 (la surface et l’humus), des colonies bactériennes situées dans les horizon B et C peuvent rentrer en contact avec les fluides aurifères en solutions aqueuses qui descendent par gravité et par capillarité ; ces bactéries peuvent avoir une certaine sensibilité par rapport à certains métaux présents cet environnement.
Les bactéries, pour se développer et prospérer, et aussi pour leurs besoins métaboliques vont profiter de la venue de ces fluides minéralisés et riches en métaux solubilisés pour vivre.
Comme je l’ai expliqué plus haut dans cet article, pour leurs besoins métaboliques, des bactéries comme le Cupriavidus metallidurans, Delftia acidovorans et Salmonella typhimurium ont développé des réponses biochimiques adaptées à la production et à la fixation de particules d’or provenant de complexes hautement toxiques riches en métaux dissouts en solutions aqueuses.
Certaines bactéries anaérobies produisent même des nanoparticules d’or, qui sont des sous-produits et des déchets des réactions métaboliques nécessaires à leurs besoins énergétiques pour vivre et prospérer.
Il a été démontré la toxicité et la nocivité de l’or présent en solution aqueuse dans les fluides environnants vis à vis desquelles les colonies bactériennes ont développé une sensibilité, c’est à dire que l’or est la plupart du temps nocif pour leurs activités métaboliques.
Pour résoudre ce problème, en réponse à cette présence d’or dans l’environnement, elles vont développer et générer des mécanismes de défenses et de résistances efficaces comme par exemple l’excrétion de substances sidérophoriques, qui vont réduire les complexes chimiques aurifères, et favoriser la précipitation de l’or dans l’environnement de proximité.
Ces substances sidérophoriques vont aussi pouvoir catalyser la biominéralisation aurifère et synthétiser des nanoparticules d’or de forme sphérique.
A ce stade, ces nanoparticules d’or ne sont pas visibles pour l’oeil humain, c’est la somme de l’accumulation de ces processus et la fusion de particules d’or entre-elles sur des durées très longues, parfois sur plusieurs milliers ou millions d’années, qui vont tendre à faire grossir ces petites particules d’or secondaire, pour les transformer en grains visibles et palpables, voire à la formation de pépites mémorables faisant la joie des chercheurs d’or et des prospecteurs d’or une fois découvertes.
Le grossissement passif des particules d’or secondaire peut avoir lieu dans le sol soit à proximité immédiate du gisement aurifère primaire (quelques mètres), soit à des distances plus importantes (10, 50, 100 mètres).
Pour mieux imaginer la genèse des grains, nuggets et pépites d’or, il est possible d’imaginer une boule de neige qui, en glissant sur une pente enneigée, devient une boule de plus en plus grosse. C’est la même idée.
Dans la Nature, les cycles du carbone, les cycles de l’azote, du soufre, et du phosphore, ainsi que les cycles des métaux et celui de l’or sont activés et dynamisés grâce aux bactéries, archées, champignons et les algues, qui jouent un rôle fondamental.
En ce qui concerne les cycles des métaux, en général, il sont conduits par des micro-organismes parce que :
- Ils peuvent avoir besoin de métaux comme micro-nutriments pour leur propre croissance cellulaire, pour se développer et prospérer ;
- Ils peuvent peuvent avoir la capacité de se procurer une source d’énergie pour leurs métabolismes à partir de la respiration cellulaire ou de l’oxydation et de la réduction des métaux ;
- Ils peuvent donner un large panel d’aptitudes de détoxification des métaux à partir de solutions aqueuses liquides riche en métaux solubilisés.
Il faut prendre aussi en considération que les paramètres géochimiques tels le pH, les conditions redox ou l’électro-conductivité peuvent être influencés et contrôlés par les micro-organismes dans leur environnement, qui ont la capacité d’influer indirectement sur les cycles des métaux.
Les bactéries contribuent à la formation, à la sécrétion et à la décomposition de ligands chimiques complexes dans les sols, dans les eaux de surface ou souterraines et dans les sédiments meubles.
Ces ligands, tels que les grandes molécules d’acides organiques, les sidérophores, les exopolymères, les cyanures et les composés soufrés, peuvent catalyser des réactions chimiques avec les métaux, y compris l’or.
Cette activité bactérienne peut influencer la solubilisation, le transport et la précipitation de l’or dans l’environnement.
Tous ces processus sont perpétuels, tant que le gisement aurifère primaire est présent, et tant que les conditions environnementales sont propices au développement de la vie, de la faune, de la flore, avec un biotope varié et un écosystème riche et diversifié.

Des bio-indicateurs pour chercher de l’or ?
Pour se protéger des la toxicité des complexes chimiques aurifères dissouts en solution aqueuse les bactéries sensibles ont mis en oeuvre comme réponse à cette agression le développement de biofilms spécifiques, dans les interstices et à la surface des grains d’or présents, dans les horizons 0, A, B, C en surface ou plus profondément dans les sols.
Les recherches scientifiques et les découvertes récentes des réponses de ces micro-organismes sensibles à la présence d’or dans l’environnement développent l’idée que des indices chimiques ou biochimiques peuvent être utilisés comme bio-indicateurs et être des outils fiables de prospections et d’explorations géologiques pour la découverte de nouveaux gisements aurifères.
Pour les prospecteurs ou les chercheurs d’or, la quantification et l’identification de certaines souches bactériennes ou de micro-organismes précis, de certains marqueurs génétiques précis dans les sols ou dans les fluides peuvent fournir des informations précieuses et utiles en tant que bio-indicateurs ou bio-capteurs dans le cadre d’analyses d’échantillons et de prélèvements sur le terrain, avec des outils et des procédés adaptés.
Lessivage / lixiviation de l’argent
Pendant très longtemps, nous pensions que l’or était un métal inoxidable, inerte, immobile, et q’il n’éxistait pas de cycle biogéochimique de l’or, ni qu’il y avait des intéractions entre l’or et les micro-organismes vivant à la surface de la terre ou plus profondément dans les sols.
Ce sont des découvertes scientifiques récentes qui ont fait évoluer cet état de fait qui implique de reconsidérer toutes nos connaissances à ce sujet, ce qui rend ce métal encore plus intéressant et les prospections aurifères plus passionnantes.
Auparavant, nous pensions que la formation de gisements aurifères d’or secondaires dans le sol et à la surface étaient provoqués par des processus abiotiques.
En écologie, les facteurs abiotiques représentent l’ensemble des facteurs physico-chimiques d’un écosystème ayant une influence sur une biocénose. C’est l’action du non-vivant sur le vivant. Les processus abiotiques sont opposables aux facteurs biotiques, qui sont des actions engendrées par le vivant.
Mais il s’avère que finalement, les grains et les pépites d’or que nous pouvons découvrir dans la Nature dans les milieux de surface sont en fait une conséquence des activités biotiques (bactéries, archées, champignons, lichen, algues, faune, flore,…)
Ce qu’il faut retenir c’est que :
- La présence d’or dans des environnements superficiels est influencée par l’action d’agents atmosphériques sur les roches qui hébergent la minéralisation primaire aurifères, c’est le weathering, c’est à dire les actions perpétuelles et incessantes de la pluie, la neige, les intempéries, le gelifraction, l’érosion, le vent, les végétaux (lichen, arbres) et par la désintégration des roches par des actions mécaniques et chimiques (acide, alcalin).
- La distribution de l’or est liée à la reconcentration, à l’accumulation physique et mécanique en certains lieux aurifères et gisements aurifères notables, comme par exemple grâce à la gravité et à l’effet Venturi (rifles, marmites, crevasses, interstices dans le bedrock).
- L’or accumule l’or et les particules d’or présentent peuvent fusionner et s’agglomérer les unes des autres, si elles sont très proches, en formant des paillettes, grains ou pépites d’or qui grossissent au fil du temps. Cette augmentation de taille est aussi une conséquence de l’apport de complexes chimiques aurifères aqueux dissouts en solution dans les fluides. Les activités des biofilms bactériens et des micro-organismes peuvent aussi contribuer au grossissement des particules d’or dans la nature.
Selon cette approche, c’est principalement l’action combinée de la mobilisation et du positionnement très rapproché des particules d’or qui permet à ceux-ci de former un plus petit nombre de particules d’or, mais de plus grande taille. Phénomènes observables dans la réalité de la prospection aurifère.
En outre, sur les paillettes et grains d’or de certaines rivières, il s’avère que les couches d’or superficielles en contact avec l’environnement direct peuvent être composées d’or très pur avec une très haute valeur de titre > 98%).
L’or Au a une forte affinité avec le métal argent Ag et s’associent souvent naturellement ensemble en proportions variables, pour créer des alliages, que l’on appelle électrum.
Dans les rivières qui charrient des grains et des paillettes d’or dans un environnement métallifère très sulfurisés (de type hydrothermal ou mésothermal), notamment avec la présence de mines et de gisements de galène argentifère en amont dans les montagnes (sulfure de plomb et d’argent), il est possible de découvrir au fond des pans et des battées de telles spécimens, en général de couleurs gris, blanc, avec des reflets dorés ou verdâtres.
D’ailleurs, une approche quantitative et le classement des paillettes et des grains d’or par couleur, et la discrimination des électrum, montrent que celles-ci peuvent correspondre à 10 à 40 % du total compté, ce qui est une proportion importante observable directement.
Cette proportion est observable dans les rivières montagneuses qui sont des nurseries à bébé or des pouponnières à particules d’or qui grossissent, à des distances de quelques kilomètres, à quelques dizaines de kilomètres de la source de gisements métallifère aurifères primaires de type sulfurés.
Plus en aval, le pourcentage d’électrum baisse considérablement, phénomène que j’ai pu observer sur différentes rivières ; dans les grands bassins sédimentaires charriés par les grands fleuves, l’électrum est plus rare que proche des gisements primaires.
La présence paillettes et de grains d’or d’électrum observables directement est un indicateur de processus bio-géochimiques et physico-chimiques sous-jacents qui permettent non seulement de créer l’alliage or-argent en tant que tel, mais l’argent lui même a un rôle dans l’augmentation de la pureté et du tire de l’or secondaire.
Comme le métal argent Ag a une plus grande possibilité d’être chimiquement dissout et solubilisé dans la Nature, il a une plus grande probabilité d’être mobilisé chimiquement à partir de l’alliage or Au – argent Ag de l’électrum des paillettes d’or.
Ce phénomène se nomme lixiviation de l’argent ou lessivage de l’argent, et peut expliquer la présence de particules d’or secondaire très pur avec un titre élevé.
Dans ce cas, l’or augmente passivement sa teneur, grâce à des apports chimiques ou bien par les rôles des biofilms bactériens, qui vont combler et remplir en or pur les vides provoqués par la lixiviation de l’argent.








Nous raisonnons ici sur des événements à la surface des paillettes et des grains d’or, directement en contact avec l’environnement extérieur, avec le substrat, ces réactions ont lieu sur les zones les plus externes.
Il faut noter aussi que l’or est polymorphe chimiquement, car il a le pouvoir de passer tantôt en solutions aqueuses sous la forme d’ions aureux (Au+1) ou auriques (Au+3), ou bien précipiter en métal pur, en or natif solide (Au0).
Ces transformations d’états chimiques de l’or auront tendance à se produire durant les saisons humides avec l’apport d’intempéries et surtout en présence de complexes chimiques organiques, matières organiques, ou de complexes -thio, comme je l’ai expliqué plus haut dans cet article.
Au contraire, pendant les épisodes de saisons arides ou sèches, ces complexes chimiques aurifères vont avoir tendance à diminuer et à être moins présents, à cause de la diminution de la présence d’eau sans les substrats et les fluides des sols et des sous-sols, ce qui provoque la précipitation de l’or solubilisé en nanoparticules d’or nanophases sous la forme de petites sphères ou de plaques de 50 nm à 200 nm.
De telles réactions s’accompagnent de la formation de minéraux par évaporation.




a) BIOTIQUE : Grain d’or dans lequel les biofilms bactériens à la surface présents dans les interstices ont tendance à dissoudre et à solubiliser l’or présent en solution aqueuses aurifères et à le disperser, le mobiliser sous forme de complexes aurifères, alimentant ainsi les les fluides environnants extérieurs. Entrainant ainsi une forme d’érosion du grain d’or.
b) ABIOTIQUE : Grain d’or sur lequel à sa surface, dans les zones les plus extérieures en contact avec le milieu environnant, se développent des réactions chimiques qui dispersent et solubilisent l’argent Ag par lixiviation ou lessivage, et qui entrainent une augmentation passive de la pureté et de la teneur en or à la surface du grain.
c) BIOTIQUE + ABIOTIQUE : Grain d’or dans lequel les processus décrits dans b) sont actifs, les biofilms bactériens et colonies bactériennes présents localement à la surface dans les dépressions et les interstices agissent en fixant l’or dissout en solution aqueuse aurifère présent dans les fluides environnants de proximité, pour créer des nanoparticules d’or qui vont remplir et combler les vides formés par la lixiviation et le lessivage de l’argent Ag. Les dépressions se comblent avec le temps, augmentant la taille du grain d’or et le faisant croitre, mais aussi en purifiant la teneur en or des couches superficielles.
Ces cycles et processus sont perpétuels.
Donc oui, finalement, si on pousse le raisonnement à l’extrême pour simplifier ces concepts :
- Les biofilms bactériens vont avoir tendance à réduire le grain d’or en taille, en utilisant le métal noble pour leurs propres processus métaboliques et prospérer, se développer et en le dispersant dans l’environnement externe sous forme de déchets et de complexes organiques aurifères, entrainant une sorte d’érosion du grain d’or;
- Les biofilms bactériens ne sont pas présents, dans ce cas l’argent présent dans l’alliage électrum Ag-Au aura tendance à être dissout par lessivage ou lixiviation de l’argent, sur les couches les plus superficielle du grain d’or. Les niveaux les plus externes du grain d’or vont avoir tendance à s’enrichir passivement en or grâce l’apport physico-chimique de l’or en solutions aqueuses aurifères présents dans les substrats et les fluides environnants, mais aussi grâce aux actions des bactéries qui génèrent des nanoparticules d’or dans le milieu environnant extérieur. Cela a pour conséquence la formation et l’accumulation de couches d’or très pures à la surface du grain d’or qui remplacent les vides formés par la lixiviation de l’argent;
- Les biofilms bactériens présents dans les dépressions vont avoir tendance à augmenter la taille du grain d’or car elles génèrent des couches polymorphes et des particules d’or au fil du temps sur les surfaces de granules d’or naturel.


C’est la somme de toutes ces interactions, réactions et processus, variables au fil du temps, et en fonction des évolutions des conditions environnementales, qui créent l’immense variété de formes et de morphologies des paillettes, grains et pépites d’or.
Rien n’est figé, et leurs états ainsi que leurs destinées évoluent en permanence, perpétuellement, c’est cela le Cycle de l’Or dans la Nature.
Minéralisations biogéniques aurifères
Dans le Cycle de l’Or les processus abiotiques jouent un rôle primordial dans les environnement de surface du sol, et de nombreuses recherches et publications scientifiques ont montré le rôle du microbiote et des micro-organismes (bactéries, archées, champignons, végétaux,…) qui peuvent interagir et être impliqués dans différentes phases du cycle biogéochimique de l’or, depuis les formations de minéralisations aurifères primaires des roches enfouies plus profondément dans les sols.
Les micro-organismes participent à la solubilisation, la dispersion, la mobilisation et la reconcentration d’or secondaire dans des environnements de surface, participant ainsi à la régénération et à la formation de gisements aurifères secondaires pouvant avoir un intérêt pour la prospection aurifère.
Les microbes colonisent en permanence les profondeurs de la Terre.
Partout dans le sous-sol, même à plusieurs kilomètres de profondeur, on trouve des colonies de bactéries et des archées.
Celles-ci s’installent dans les zones où la roche est fragile et perméable, comme les failles.
Dans les roches sédimentaires poreuses et les roches métamorphiques perméables (peu transformées), elles forment de véritables colonies qui prospèrent et se développent durablement.
Ces micro-organismes pourraient même jouer un rôle essentiel dans la formation de certains gisements métallifères et dans la formation de minerais exploitables.
Ils pourraient jouer un rôle vital dans l’enrichissement et la concentration localisés des éléments suivants :
fer, fluor, manganèse, calcium, le magnésium, le potassium, le sodium, les métaux (par exemple : argent, molybdène, chrome, cuivre, nickel, palladium, sélénium, tungstène, vanadium, uranium et or).
Les micro-organismes ont un rôle fondamental d’un point de vue métallogénique dans les failles des gisements aurifères primaires des roches mères et peuvent prospérer dans les champs aurifères hydrothermaux à basse et moyenne température, favorisant la précipitation, solubilisation et la mobilisation de l’or, et pouvant créer localement des zones avec des fortes concentrations et teneurs en or exploitables et identifiables.
Ci-dessous: d’autres vues détaillées de grains et de paillettes d’or, prises au microscope optique binoculaire, illustrant l’incroyable panoplie des formes possibles.




















Conclusions
Voilà qui est fait, enfin, j’ai bouclé cet article, après plus d’un an de travail !
Je suis heureux car ce sujet me tenait à coeur, et je souhaitais vous le faire partager au plus grand nombre.
Comme nous avons pu le voir, de nombreuses bactéries, microbes et micro-organismes ont la possibilité de solubiliser et de précipiter activement l’or, et ils jouent un rôle essentiel dans la dispersion et la concentration de l’or dans la nature, aussi bien en surface, que dans le sous-sol profond, ainsi que dans les zones hydrothermales.
Les prospecteurs doivent intégrer et prendre en compte les concepts du Cycle bio-génique le l’Or, dans le cadre de leurs prospections aurifères, et surtout respecter et prendre soin des environnements naturels et des biotopes, qui sont les moteurs de la formation de gisements aurifères secondaires.
Les activités microbiennes expliquent pourquoi l’or se renouvelle continuellement et perpétuellement dans les placiers aurifères de nos rivières, mais aussi, pourquoi l’or secondaire est plus pur et fin que l’or primaire.
Il faut retenir aussi que les micro-organismes (bactéries, microbes, archées, champignons, bio-films):
- interviennent dans la solubilisation de l’or par la formation de complexes chimiques aureux ou auriques en solutions aqueuses (chlorure, thiosulfate, acides aminés, cyanure);
- ont développé des réponses génomiques et biochimiques directes pour traiter les complexes d’or toxiques grâce à des enzymes spécifiques et d’autres substances et mécanismes;
- sont capables de précipiter l’or intra- et extra-cellulaire, et dans les produits de leur métabolisme (minéraux sulfurés);
- fabriquent un sous-produit et un résidu composé de nanoparticules d’or, qui auront tendance à être libéré, à grossir et à croitre au fil du temps;
- sont capables non seulement de transporter l’or en solution ou en particules (parfois sur de très longues distances), mais aussi de le faire accumuler et croitre, formant des concentrations potentielles sous la forme de placiers d’or secondaire.
La présence d’espèces bactériennes tend à maximiser ces processus en favorisant durablement le système du Cycle de l’Or ; sans ces micro-organismes, sans la flore et la faune microbienne, il y aurait moins de particules d’or mais aussi moins de placiers et de gisements d’or secondaire.
Une fois que les roches composées de minéralisations primaires restent exposées aux éléments environnants (weathering, pluie, vent, érosion, oxygène), cela entraine la désintégration mécanique et donc la dispersion des minéraux contenant de l’or dans la nature.
Les activités bactériennes et microbiennes vont ensuite désintégrer ces minéraux (comme la pyrite, la galène, la chalcopyrite, l’arsénopyrite…), et cela va libérer l’or s’il est présent.
Enfin, pour résumer, les micro-organismes, les bactéries et les microbes ont les facultés suivantes:
- Identifier la présence d’or dans les complexes environnants (activité sensorielle) et développer des réponses biologiques et chimiques pour se protéger de la toxicité de l’or;
- Procéder à la production des substances chimiques qui permettront à l’or de précipiter et d’apparaître dans un état solide sous la forme de nanoparticules. Les bactéries créent une protection afin de diminuer la toxicité environnementale induite par l’or (biofilm);
- Assimiler des complexes chimiques aureux ou auriques afin d’utiliser ses composants pour ses propres activités métaboliques. Ainsi, l’or précipite à la fois à l’intérieur et à l’extérieur des micro-organismes;
- Assimiler les complexes d’or afin d’utiliser le métal lui-même pour ses activités métaboliques. Dans ce cas, l’or précipite car il est réduit par l’activité bactérienne ou il est ensuite traité comme un déchet, un sous-produit, qui sera éjecté en dehors dans l’environnement de proximité.
L’activité bactérienne ouvre de nouvelles frontières d’un point de vue scientifique, mais aussi dans le cadre de la recherche et de la prospection aurifère ; aussi rappelons que certaines populations de micro-organismes peuvent jouer le rôle d’espèces bio-indicatrices.
La toxicité des complexes d’or favorise le développement de biofilms spécialisés sur les grains d’or présents.
Le Cycle de l’Or est un processus perpétuel qui est actif aussi bien dans les milieux de surface, que dans les sols enfouis profondément.
La découverte de réponses microbiennes spécifiques à la présence d’or peut le conduire développement d’outils d’exploration géobiologique (bio-indicateurs d’or et biocapteurs).
Les bio-indicateurs utiliseraient des marqueurs génétiques des sols et des eaux souterraines pour fournir des informations sur les processus de minéralisation aurifère tandis que les bio-capteurs permettrait des analyses sur le terrain des concentrations d’or dans les zones d’échantillonnage.
J’espère que cet article vous aidera à mieux comprendre certains concepts du Cycle de l’Or dans la nature, et aussi que vous observerez la Nature sous un autre oeil, avec l’humilité et le respect qui simpose.
je vous remercie pour votre patience, et pour votre confiance et vous souhaite le santé et le bonheur. Ne lâchez rien !

Références
Web
- Comment trouver de l’or dans les rivières? Article ici: https://www.goldlineorpaillage.fr/comment-trouver-or-riviere/
- Comment lire une rivière pour trouver de l’or? Article ici: https://www.goldlineorpaillage.fr/lire-riviere-orpaillage/
- Comment bien prospecter un placer pour trouver de l’or? Article ici: https://www.goldlineorpaillage.fr/comment-prospecter-placer-banc-graviers/
- Orpaillage : Les 53 astuces et conseils du chercheur d’or. Article ici: https://www.goldlineorpaillage.fr/trucs-astuces-orpaillage/
- Comment prospecter et trouver de l’or en rivière? Article ici: https://www.goldlineorpaillage.fr/comment-trouver-or-riviere/
- Les placier alluviaux. Article ici: http://www.orpaillage.fr/placer/placers_alluviaux.html
- Orpaillage, où chercher et trouver de l’or ? Article ici: https://ilovedetection.com/orpaillage-ou-chercher-de-lor/
Thèses
- WINOGRADSKY REVIEW – The geomicrobiology of gold écrit par les auteurs Frank Reith, Maggy F Lengke, Donna Falconer, David Craw et Gordon Southam. Lien ici.
- Geobiological Cycling of Gold: From Fundamental Process Understanding to Exploration Solutions, par les auteurs Frank Reith,, Joël Brugger, Carla M. Zammit, Dietrich H. Nies et Gordon Southam. Autre lien ici.
- Reflecting on Gold Geomicrobiology Research: Thoughts and Considerations for Future Endeavors écrit par les auteurs Jeremiah Shusteret Frank Reith. Autre lien ici et ici.
- Nanoparticle factories: Biofilms hold the key to gold dispersion and nugget formation, rédigé par les scientifiques Frank Reith, Lintern Fairbrother, Gert Nolze, Oliver Wilhelmi, Peta L. Clode, Adrienne Gregg, John E. Parsons, Steven A. Wakelin, Allan Pring, Robert Hough, Gordon Southam et Joel Brugger. Article disponible ici.
- Mechanisms of gold biomineralization in the bacterium Cupriavidus metallidurans , une thèse signée par Frank Reitha, Barbara Etschmannc, Cornelia Grossef, Hugo Moorsg, Mohammed A. Benotmaneg, Pieter Monsieursg, Gregor Grassh, Christian Doonani, Stefan Vogtj, Barry Laij, Gema Martinez-Criadok, Graham N. Georgel, Dietrich H. Niesf, Max Mergeayg, Allan Pringc, Gordon Southamm, et Joe ̈ l Brugger. Document disponible ici, ici et ici.
- Geochemistry of gold in the weathering cycle, par Hubert W. Lakin, Gary C. Curtin et Arthur E. Hubert, du Geological Survey Bulletin 1330, publié en 1974: https://pubs.usgs.gov/bul/1330/report.pdf (en version PDF).
- The effect of thiosulfate-oxydizing bacteria on the stability of the gold-thiosulfate complex, par Maggy F. Lengke et Gordon Southam, publié par le Department of Sciences, University of Western Ontario, Canada, publié en 2004: https://www.researchgate.net/publication/222679505_The_effect_of_thiosulfate-oxidizing_bacteria_on_the_stability_of_the_gold-thiosulfate_complex (Sur Researchgate.net)
- Bioaccumulation of gold by sulfate-reducing bacteria cultured in the presence of gold(I)-thiosulfate complex, par Maggy Lengke et Gordon Southam, publié dans la revie ELSEVIER en 2006: https://www.researchgate.net/publication/251309189_Bioaccumulation_of_gold_by_sulfate-reducing_bacteria_cultured_in_the_presence_of_goldI-thiosulfate_complex (Sur Researchgate.net)
- Biosynthésis of gold nanoporticles: a review, par Maggy F. Lengke, Charoen Sanpaxanitchakit, et Gordon Satham, en 2011: https://www.researchgate.net/publication/226101864_Biosynthesis_of_Gold_Nanoparticles_A_Review (Sur Researchgate.net)
- Cupriavidus metallidurans: evolution of a metal-resistant bacterium, par Von Rozycki et Nies DH, source PUBMED: https://www.researchgate.net/publication/23295319_Cupriavidus_metallidurans_Evolution_of_a_metal-resistant_bacterium
- The in vitro formation of placer gold by bacteria, écrit par Gordon Southam et Terrance J. Beveridge, du Department of Biological Sciences en Arizona, en 1994: https://www.sciencedirect.com/science/article/abs/pii/0016703794903557
- Exploitation of marine bacteria for production of gold nanoparticles, écrit par Nishat Sharma, Anil Kumar Pinnaka, Ashish Ashish, Manoj Raje, et publié en 2012 par Researchgate.net: https://www.researchgate.net/publication/227707127_Exploitation_of_marine_bacteria_for_production_of_gold_nanoparticles
- Natural gold particles in Eucalyptus leaves and their relevance to exploration for buried gold deposits relevance to exploration for buried gold deposits, par Melvyn Lintern, Ravi Anand, Chris Ryan, David Paterson, publié en 2013 par la revue Nature: https://www.nature.com/articles/ncomms3614
- The smallest gold-diggers in the world, écrit par Richard Noorden, publié en 2006, dans le revue Nature: https://www.nature.com/news/2006/060710/full/060710-13.html
- Gold-digging bacterium makes precious particles, par Ewen Callaway publié dans la revue scientifique NATURE, en 2013: https://www.nature.com/news/gold-digging-bacterium-makes-precious-particles-1.12352
- Bacteria produce gold by digesting toxic metals, par Martin-Luther-Universität Halle-Wittenberg: https://phys.org/news/2018-02-bacteria-gold-digesting-toxic-metals.html
- Fungus that draws gold from its surroundings discovered in Western Australia, écrit par CSIROpublié par THE GUARDIAN: https://www.theguardian.com/science/2019/may/24/fungi-that-draws-gold-from-its-surroundings-discovered-in-western-australia
- Gold particles in Eucalyptus trees can reveal deposits deep underground, écrit par Joseph Sttomberg, et publié en 2013: https://www.smithsonianmag.com/science-nature/gold-particles-in-eucalyptus-trees-can-reveal-deposits-deep-underground-3481702/
- Researchers Discover Bacteria That Produces Pure Gold, par Geologyin: https://www.geologyin.com/2016/03/researchers-discover-bacteria-that.html
- Pour trouver de l’or, suivez ce champignon !, écrit par Céline Deluzarche, journaliste, publié en 2019 dans FUTURA SCIENCES: https://www.futura-sciences.com/planete/actualites/geologie-trouver-or-suivez-ce-champignon-43373/
- Gold dissolution from ore with iodide-oxididing bacteria, de Sann Yee Khaing, Yuichi Sugai et Kyuro Sasaki, publié par Researchgate.net: https://www.researchgate.net/publication/331689359_Gold_Dissolution_from_Ore_with_Iodide-Oxidising_Bacteria
- Evidence of fungi and gold redox interaction under Earth surface conditions, publié en 2019 par la revue scientifique Nature: https://www.natureindex.com/article/10.1038/s41467-019-10006-5
- Enhancing gold recovery from electronic waste via lixiviant metabolic engineering in Chromobacterium violaceum, par Song Buck Tay, Gayathri Natarajan, Ht Tan, Muhammad Nadjad bin Abdul Rahim, publié sur Researchgate.net: https://www.researchgate.net/publication/250920355_Enhancing_Gold_Recovery_from_Electronic_Waste_via_Lixiviant_Metabolic_Engineering_in_Chromobacterium_Violaceum
- Lamprophyres a source of gold, écrit par D. Wyman et R. Kerrich en 1988 dans Nature: https://www.nature.com/articles/332209a0.pdf?origin=ppub
- Une bactérie qui vaut de l’or, publié par Joël Ignasse dans SCIENCES ET AVENIR: https://www.sciencesetavenir.fr/nature-environnement/une-bacterie-qui-vaut-de-l-or_9650
- Les anciennes mines de plomb argentifère de l’Ariège, par Claude Dubois, publié en 1997: https://www.persee.fr/doc/palla_0031-0387_1997_num_46_1_1445 (Sur Persee.fr)
- Mesozoic vein-type Pb-Zn mineralization ine the Pyrennees: lead isotopic and fluid inclision evidence from the Les Argentières and Lacore deposits, écrit par Marguerite Munoz, Sandrine Baron, Adrien Boucher et didier Béziat, publié en 2015 par GEOSCIENCE dans ELSEVIER: https://www.sciencedirect.com/science/article/pii/S163107131500098X
- Les principaux niveaux minéralisés (Zn, Pb, Cu, Ba) du Paléozoïque des Pyrénées centrales: éléments de synthèse, par Georges Pouit, Christian Boucquet et Jean-Pierre Bois, en 1979 par le BRGM.
- Arrens Zn (Pb), Ba Devonian deposit, Pyrénées, France: an exhalative-sedimentary-type deposit similar to Meggen, par G. Pouit & J.-P. Bois, en 1986: https://link.springer.com/article/10.1007/BF00199798
- Place des métaux stratégiques dans l’histoire hercynienne des Pyrénées: l’exemple du dôme de Bossost (Haute-Garonne), par Alexandre Cugerone en 2016: http://rgf.brgm.fr/sites/default/files/upload/documents/production-scientifique/Masters/rgf_amipyr2015_ma1_memoire_cugerone.pdf
- Revalorisation du potentiel minier français Revue et cartographie prédictive pour W, Au et Ge dans les Pyrénées, par le BRGM en 2016: http://www.mineralinfo.fr/sites/default/files/upload/documents/Rapports_BRGM/revue_et_cartographie_predictive_pour_w_au_et_ge_dans_les_pyrenees.pdf
- Les minéralisations ZN-Pb exhaltives sédimentaires de Bentaillou et de l’anticlinorium paléozoïque de Bosost (Pyrénées ariégeoises, France), par Georges Pouit, publié en 1986.
- Les minéraux en trace de Ni-Co, Sn, Ge-Ga, Pb-Sb, Ag et Au témoins de l’évolution de l’hydrothemalisme de l’Ordovicien au Dévonien dans les minéralisations zincifères des Pyrénées Centrales, par Elisabeth Oudin, Georges Pouit, Francis Tollon, en 1988: https://www.persee.fr/doc/bulmi_0180-9210_1988_num_111_1_8070
- Note sur le gisement de zinc et plomb de la concession de Sentein et Saint-Lary (Ariège), par Jean Lougnon, publié en 1954 par le BRGGM.
- La minéralisation des Pyrénées Centrales par E. Oudin, rapport du BRGM publié en 1982: http://infoterre.brgm.fr/rapports/82-SGN-189-MGA.pdf
- Inventaire et typologie des minéralisations du Paléozoïque des Pyrénées (Zone Nord et Est de Bassies – France) par G. Pouit, publié par le BRGM en 1982: http://infoterre.brgm.fr/rapports/82-SGN-668-GMX.pdf
Livres
Histoire et archéologie:
- Premier mémoire sur l’or retiré de l’Ariège, de DIETRICH (DE) Baron, des éditions Lacour Rediviva. Disponible ici.
- Ariège – Pyrénées MUSSY (M.), 1864 – Gîtes métalliques du Saint-Gironnais, Pages 80, 81, 82,83, disponible ici.
- Les ressources minérales de l’Ariège de M. MUSSY, 1ère et 2ème partie, disponibles ici et ici.
- Au Pays des Hommes et du Fer, le livre intitulé Richesses et exploitations minières en Ariège, Tome 1 et Tome 2, du géologue Henri Tabarant. Il sont devenus introuvables.
- Etudes historiques sur l’ancien pays de Foix et le Couserans, de Adolphe Garrigou, 1856, des éditions Lacour Rediviva. Disponible ici.
- Etudes historiques sur l’ancien pays de Foix et le Couserans limites de l’ancienne Aquitaine et de la Province Romaine du temps de Jules César, de Adolphe Garrigou, 1856, des éditions Lacour Rediviva. Disponible ici.
- Vallées ariégeoises avant l’invasion romaine, de Adolphe Garrigou, 1856, des éditions Lacour Rediviva. Disponible ici.
- Le gisement et le traitement direct des minerais de fer dans les Pyrénées & l’Ariège (Ed 1843), Hachette Livre, BNF, de Jules François.
- Dans les cavernes des Pyrénées ariégeoises, par F. Garrigou, de Tarascon (Ariège) et H. Filhol, des éditions Lacour/Rediviva, en 1998: http://www.editions-lacour.com/
- La mine de cuivre gallo-romaine du Goutil, à la Bastide-de-Sérou (Ariège), par Jean-Emmanuel Guilbaut, en 1981: https://www.persee.fr/doc/galia_0016-4119_1981_num_39_1_1826
- Les mines de plomb argentifère et zinc d’Aulus-les-bains (Ariège), de Claude Dubois: https://www.persee.fr/doc/amime_0758-7708_1999_num_17_1_928
Livres:
- Je vous recommande chaudement tous les livres du spécialiste et prospecteur italien Matteo Oberto, qui sont des références dans le domaine de la recherche aurifère, ce sont des ouvrages de très grande qualité! Vous pourrez tous les trouver ici, en langue anglaise ou italienne.
- Le livre français édité par le b, écrit par Christian Guiollard, et intitulé le Guide pratique du chercheur d’or en France, cet ouvrage est le minimum requis. Il y a un large chapitre de cours sur l’or alluvionnaire. Disponible sur le site de la Fnac.
- Roches et paysages, reflets de l’histoire de la Terre, de François Michel, des éditions du BRGM: https://www.amazon.fr/Roches-paysages-Reflets-lhistoire-Terre/dp/2701140811
- Le livre américain intitulé Handbook For Gold Prospectors in Washington, écrit par WAYNE S. MOEN and MARSHALL T. HUNTTING, en 1975. Lien du PDF ici: http://www.dnr.wa.gov/Publications/ger_ic57_handbook_gold_prospectors.pdf
- Un excellent document intitulé Placers and gold déposits in Arizona, rédigé en langue anglaise, écrit par MAUREEN G. JOHNSON, en 1972. Lien du PDF ici: https://pubs.usgs.gov/bul/1355/report.pdf
- Je vous recommande aussi la lecture attentive du livre sur l’orpaillage de P. Proust, datant de 1920, intitulé Prospection, gisements, extraction de l’or, des éditions Gauthier-Villars et Cie. Livre disponible ici.
- Handbook of gold exploration and evaluation, écrit par Heoin H. Macdonald, disponible en PDF ici:
- L’excellent guide Larousse intitulé Quelle est cette roche? de l’auteurTom JACKSON. Disponible ici.
- Roches et minéraux, des éditions SAEP, écrit par Hervé Jacquemin et Hervé Sider. Disponible ici.
- Le livre intitulé Rock Identification Field Guide, de Patrick Nurre, des éditions Northwest Treasures Geology, publié en 2013. Disponible ici.
- Un second livre de Patrick Nurre, intitulé Rock Identification Made Easy, des éditions Northwest Treasures Geology en 2014. Disponible ici.

NB. Pour des raisons évidentes de préservation des lieux sauvages et des biotopes, je ne divulguerai pas les localisations précises de mes recherches.
Car je tiens à conserver en l’état et à l’abris des curieux, des touristes, des fâcheux, de vénaux ou des mercantiles ces endroits magnifiques et magiques.
Si vous orpaillez, rebouchez vos trous! Respectez l’environnement et ne laissez aucune trace de votre passage!
Copyrights: ©Vivien Laïlle / ©Goldsnoop.com 2024, droits réservés.
Crédits photographiques: ©Vivien Laïlle / ©Wikipedia

